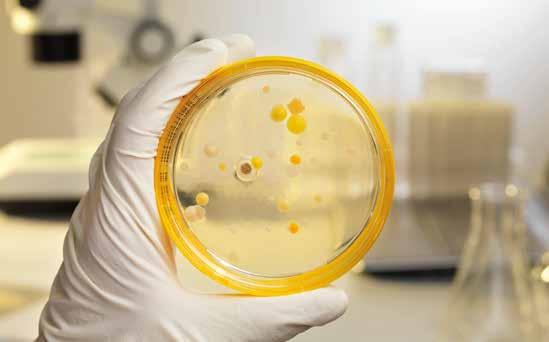

Entrevista: Consultor de DNB Bank, Dag Sletmo Balance
![]()

Entrevista: Consultor de DNB Bank, Dag Sletmo Balance
Entrevista: Presidente de SalmonChile, Arturo Clément






La nueva fileteadora MS 2750 de Marel ofrece extraordinaria durabilidad, flexibilidad y conectividad llevando el fileteado de salmón al siguiente nivel.
• Alimentación y recorte automáticos
• Ajuste dinámico de las cuchillas
• Diseño robusto e higiénico marel.com/nueva-ms2750







El salmón chileno mantuvo el segundo puesto entre los productos de exportación de Chile, generando un 17% de las divisas no mineras, mostrando un importante auge del coho en Brasil y Japón, lo que, sin embargo, no representa una alegría para el sector.

En entrevista con Revista AQUA, el presidente de SalmonChile, Arturo Clément, desgrana la estrategia público-privada que debe tomar el país para cuidar los 86.000 empleos que brinda la industria, eliminar “aranceles invisibles” y proyectar un crecimiento sostenible para la salmonicultura chilena.
5 Editorial
6 El salmón chileno en 2024: Entre la resiliencia y los nuevos desafíos
12 Industria mitilicultora: Analizan producción de 2024 y se alistan para el 2025
16 Salmonicultura en Aysén: Desafíos y oportunidades convergen en AquaForum Aysén
20 AquaForum Aysén 2025: Instantes que marcaron a la industria patagónica
23 Algas marinas en Chile: Crecimiento, exportaciones y sostenibilidad
28 Presidente de SalmonChile, Arturo Clément “La sustentabilidad no es una opción, es parte integral de nuestra competitividad”
32 Consultor de DNB Bank, Dag Sletmo “El consumidor estadounidense tendrá que pagar los aranceles”
35 Acuicultura + Pesca
38 Recuperación de fondos marinos: Soluciones frente a la nueva regulación
42 Plantas de proceso acuícola: Avances en bioseguridad y desinfección
46 De residuo a oportunidad: El reciclaje y la remanufactura en la acuicultura chilena
50 Acuerdos de Producción Limpia: Avances hacia una acuicultura más sostenible
54 Situación de pesquerías: El análisis de los recursos tras el último periodo
59 Cifras de la industria: Tomando el pulso a la acuicultura
61 Negocios
64 Nuestra Revista

El consultor de DNB Bank, el mayor grupo financiero de Noruega, conversa con Revista AQUA respecto de los alcances de los aranceles estadounidenses para los países productores de salmón.
Consejo Editorial: Director: Cristián Solís, Francisco Renner (SalmonChile), Juan Luis Amenábar (Consejo del Salmón), Fernando Villarroel (Mowi), Mauricio Delgado (Australis), Alfredo Tello (Camanchaca), Francisco Lobos (Multi X) y Ricardo Arriagada (ProChile)
B2B MEDIA GROUP
Gerente General: Cristián Solís A. (csolis@b2bmg.cl)
• Editor: Rodrigo Álvarez (ralvarez@b2bmg.cl) • SubEditor Técnico: Cristian Alvial (calvial@b2bmg.cl) • Periodista: Josefa Watson (jwatson@b2bmg.cl) • Gerente TI: Oscar Sánchez (osanchez@ b2bmg.cl) • Gerente Inteligencia Mercados: Luis Ramírez (lramirez@b2bmg.cl) • Gerente Administración y Finanzas: Alex Céspedes (acespedes@b2bmg.cl) • Encargado Suscripciones: Rubén Villarroel (rvillarroel@b2bmg.cl) • Fotografía: Archivo B2B Media Group • Diseño Gráfico y Producción: Alejandra Barraza (alebarraza.diseno@gmail.com) • Impresión: Gráfica Andes. Los artículos de opinión son de responsabilidad de los autores y no implican necesariamente que los editores comparten los conceptos emitidos.


El salmón chileno volvió a coronarse en 2024 como la segunda mayor exportación del país, con 782.077 t embarcadas y US$6.371 millones en divisas. Pero detrás del titular hay señales de alerta: El valor FOB cayó 1,4% frente a 2023 y se ubica 3,4% bajo el récord de 2022. A la desaceleración de precios se sumó el impacto del arancel base de 10% que Estados Unidos impuso el 5 de abril, golpe directo sobre el 42% de los despachos de la industria. Si algo dejó claro este desafío que se vive actualmente -tarifa externa, burocracia interna y escrutinio reputacional-, es que ya no basta con la capacidad individual de las compañías para resistir los ciclos, abriéndose la necesidad de generar un nuevo pacto político-privado que defienda la competitividad global del salmón y, al mismo tiempo, cure sus males domésticos.
La idea no es teórica. El presidente de SalmonChile, Arturo Clément, lo planteó sin rodeos: “Estamos colaborando con el gobierno para establecer una estrategia país que aborde este desafío. No es un tema sectorial, es un desafío que requiere unidad nacional. Proponemos conformar un equipo negociador de excelencia que combine lo mejor del sector público y privado -un dream team- para presentar una posición sólida ante Estados Unidos”.
La urgencia es doble. En el frente externo, Chile debe mostrar a Washington que protege la propiedad intelectual, refuerza la trazabilidad sanitaria y asegura abastecimiento confiable. Pero hacer lobby sin resolver los desafíos en casa resultaría estéril. Los llamados “aranceles invisibles”
-permisología, la necesidad de modernizar procesos administrativos y de generar mayor certeza jurídica para las inversiones- drenan más competitividad que muchos gravámenes formales. El último balance del Consejo del Salmón retrata una industria estancada en volumen desde 2022 y con márgenes bajo presión. Noruega, en contraste, proyecta quintuplicar su oferta a 2050. Seguir jugando a reglamentos parcelados solo profundizará la brecha.
Bajo ese prisma, el pacto que se propone se sustenta en una estrategia integral que combine, por un lado, una defensa comercial unificada y, por otro, una reingeniería regulatoria que agilice los trámites mediante una ventanilla única digital, capaz de recortar en un tercio los tiempos de obtención de concesiones y permisos ambientales. A esto se suma una agenda de innovación orientada a incentivos tributarios que fomenten nuevas tecnologías.
Los beneficios sociales de una alianza de este tipo van más allá de la competitividad: La salmonicultura ha sido motor de descentralización y movilidad social, generando decenas de miles de empleos de calidad y oportunidades para miles de pymes en el sur de Chile. Sin embargo, el desafío actual exige pasar del diagnóstico a la acción coordinada y renovar el vínculo público-privado que permitió los grandes saltos del pasado.
La historia económica reciente demuestra que Chile avanza cuando el Estado y el sector productivo reman hacia la misma orilla; así ocurrió con la apertura comercial de los noventa. Hoy, el salmón requiere el mismo enfoque concertado. Mover este barco tendrá un costo, pero dejarlo a la deriva sería mucho más caro. No se trata solo de sortear un arancel del diez por ciento, sino de convertir al salmón en emblema de una economía inteligente, descentralizada y verde.


El salmón chileno en 2024
EL SALMÓN CHILENO MANTUVO EL SEGUNDO PUESTO ENTRE LOS PRODUCTOS DE EXPORTACIÓN DE CHILE, GENERANDO UN 17% DE LAS DIVISAS NO MINERAS, MOSTRANDO UN IMPORTANTE AUGE DEL COHO EN BRASIL Y JAPÓN, LO QUE, SIN EMBARGO, NO REPRESENTA UNA ALEGRÍA PARA EL SECTOR.

El salmón chileno se ha vuelto a posicionar como el segundo producto exportador de la balanza comercial nacional durante 2024, aportando en el periodo el 6% del valor FOB total exportado por Chile y concentrando el 17% de las divisas generadas por productos no mineros, muy por encima de cerezas y celulosa (9% cada uno), según datos emanados desde Aduana.
Esta relevancia convierte a la salmonicultura en la locomotora de las economías de Los Lagos, Aysén y Magallanes, donde la actividad articula cadenas que van del cultivo y procesamiento a los servicios logísticos, sanitarios y de investigación aplicada, impulsando clústeres de innovación acuícola a lo largo de la macrozona sur.
Sin embargo, estas cifras no representan una alegría para el sector. Las exportaciones, que totalizaron 782.077 toneladas, fueron apenas 0,9 % más altas que en 2023, pero generaron US$6.371 millones, lo que implica un 1,4% menos interanualmente y un 3,4% por debajo del pico de 2022.
En conversación con Revista AQUA, el director de Comercio Internacional del Consejo del Salmón, Pablo Barahona explica estas cifras mencionando que “la baja en el valor FOB de las exportaciones de salmón chileno en 2024 obedece a una combinación de factores. En primer lugar, una estabilización de los volúmenes productivos con un alza marginal de 0,9%, lo que limitó el crecimiento por volumen. Segundo, un ajuste en los precios internacionales de algunos mercados. Y tercero, la anticipación del arancel del 10% en EE. UU., sumado a condiciones macroeconómicas globales menos dinámicas. Este conjunto de elementos impactó los ingresos totales pese a un desempeño estable en producción”.
En la serie 2017-2024 de los principales productos exportados por el país en el periodo, elaborada por el Consejo del Salmón sobre la base de los datos de Aduanas, se muestran volúmenes dentro del rango 705.000 - 783.000 t y valores cercanos a US$6.000 millones, salvo el salto coyuntural de 2022. En este sentido, desde el gremio advierten que “la caída en ingresos desde 2022 alcanza un –3,4 %, lo que da cuenta de un escenario que obliga a incrementar la competitividad y la eficiencia para sostener los márgenes frente a mercados cada vez más exigentes”.
La trayectoria sectorial exhibe un avance continuo entre 2017 y 2021, cuando las toneladas exportadas subieron de 585.000 a 779.000, impulsadas por mejoras en eficiencia alimenticia y control de parasitosis. Desde 2022 la curva se aplanó: El volumen permanece casi invariable, reflejando restricciones de biomasa y la madurez de los centros operativos. Paralelamente, los valores FOB se resintieron pese a los altos precios internacionales, afectados por sobrecostos sanitarios y logísticos derivados de floraciones algales, mortalidades masivas y la prolongada disrupción de las cadenas de suministro marítimas.
Sin embargo, durante 2024 los datos muestran que la producción alcanzó unas 700.000 t, con un ligero crecimiento de 0,9%. Consultado respecto del por qué, si bien la producción crece marginalmente, los ingresos caen, Barahona explica que “el desfase entre producción e ingresos es natural en ciclos
“Las decisiones de siembra se tomaron en condiciones de mercado distintas a las actuales. Aumentar volumen permite mantener presencia en mercados estratégicos, aun cuando los precios unitarios hayan bajado”, sostiene el director de Comercio Internacional del Consejo del Salmón, Pablo Barahona.
Enero-Diciembre
Fuente: InfoTrade
“Por ejemplo, en 2020 las exportaciones a ese destino totalizaron US$409 millones y ya en 2024 estos alcanzan US$915 millones, un crecimiento sostenido del 124% en solo cinco años”, expresa sobre Brasil el director de la Macrozona Sur de ProChile, Ricardo Arriagada.
productivos largos como el del salmón. Las decisiones de siembra se tomaron en condiciones de mercado distintas a las actuales. Aumentar volumen permite mantener presencia en mercados estratégicos, aun cuando los precios unitarios hayan bajado. En este sentido, es importante destacar las estrategias que las empresas realizan en sus procesos para mantener los volúmenes, las cuales van desde la implementación de tecnologías avanzadas, prácticas de manejo más eficientes y una significativa reducción en las tasas de mortalidad”.
MERCADOS EN MOVIMIENTO: EE. UU. RETROCEDE Y BRASIL ANOTA RÉCORD
Durante 2024, Estados Unidos se mantuvo como el principal destino de los salmónidos chilenos con 235.934 t, lo que representa un 30% del total. Sin embargo, los embarques cayeron 7% en volumen y 8% en valor (-US$226 millones) a causa de la mayor competencia del salmón noruego fresco y la normalización del consumo pospandemia. Japón, por su parte, revirtió la tendencia del año anterior, anotando un +14%, hasta
157 445 t (20%), apoyado en la reapertura del canal horeca y la apreciación del yen. Brasil encadenó su séptima alza en ocho años: 146 597 t (+8%), dejando atrás la contracción de 2022 causada por restricciones logísticas.
“Estados Unidos sigue siendo nuestro principal mercado. Esta retracción se debe a factores como ajustes en inventarios pospandemia, una leve desaceleración del consumo en ciertas categorías, y la presión de mayores costos logísticos. A pesar de esta caída en volumen, cabe destacar que un alto porcentaje de lo exportado corresponde hoy a productos con valor agregado, como porciones, lo que mantiene fuerte el posicionamiento del salmón chileno en EE. UU.”, comenta al respecto de los resultados el ejecutivo del Consejo del Salmón.
China (5%), Rusia (4%), México y Vietnam (2% cada uno) completan el grupo principal, seguidos por otros 70 mercados que juntos absorben 16% restante. En 2024 destacaron los aumentos de Vietnam y Corea del Sur—vía reexportación de coho—y la resiliencia de Rusia, que mantuvo el abastecimiento pese a la volatilidad logística derivada de la guerra en Ucrania.
Para el director de la Macrozona Sur de ProChile, Ricardo Arriagada, los resultados del mercado de Brasil, “más que cobrar relevancia, es un mercado que ha destacado por el crecimiento que han experimentado los envíos de salmón. Por ejemplo, en 2020 las exportaciones a ese destino totalizaron US$409 millones y ya en 2024 estos alcanzan US$915 millones, un crecimiento sostenido del 124% en solo cinco años”.
ProChile apoya a la promoción sectorial de productos del mar, dentro del cual, el principal subsector exportador es la salmonicultura, a través de distintas acciones alrededor del mundo. Durante 2024, por ejemplo, la principal actividad para el sector fue “la realización en Puerto Varas de la Enexpro Productos del Mar 2024, donde, a través de una rueda de negocios, se reunieron empresas exportadoras de todo Chile con 29 importadores de 21 mercados, generando una proyección de negocios de US$124 millones”, comenta Arriagada.
“Para el año 2025, ProChile ya ha estado presente con un pabellón de Chile con empresas exportadoras en la Seafood Expo North América (16 al 18 de marzo); Seafood Expo Global 2025 en España (6 al 8 de mayo) y tiene planificado participar en la Feria China Fisheries Seafood Expo 2025 (29 al 31 de octubre)”, continua.
Enero-Diciembre 2024
Fuente: InfoTrade
Además, en abril se realizó en Ciudad de México, el evento “Del Mar a la Mesa: Masterclass y exhibición de productos del mar”, donde se promocionaron distintos productos, dentro de los cuales estaba el salmón, a contrapartes del canal horeca de México. “También se llevó a cabo una misión comercial de exportadores de Productos del Mar a Lituania y Polonia,y en junio se realizará la semana del mar en la Expo Osaka 2025, en la que, dentro de distintas actividades, se considera la organización de un seminario, actividad de networking y tasting show”.
El salmón Atlántico (Salmo salar) siguió liderando la canasta con 524.384 t (67 %), pero retrocedió 5,4% respecto de 2023. El salmón Pacífico o coho escaló 19,5 % y alcanzó 220.435 t (28%), impulsado por el mayor consumo en Japón y la diversificación hacia Brasil y EE. UU. La trucha arcoíris aportó 37.257 t (5 %), sosteniendo su nicho en mercados europeos y latinoamericanos.
Con respecto a los formatos, las preferencias de los consumidores dictan la logística: El 64,6% del salmón Atlántico se envió fresco -principalmente filetes Trim-D y porciones-, frente a un 34,8% congelado y un 0,6% ahumado destinado al retail premium. En coho, el 96,8 % salió congelado (H&G o filete) y solo el 3,1% viajó fresco, opción adaptada al calendario estacional japonés y a la necesidad de asegurar consistencia organoléptica.
Según datos del Consejo del Salmón, un kilogramo de filete fresco Atlántico suele cotizarse 20% por encima del producto congelado, mientras el coho compensa con mayores volúmenes y menores costos logísticos gracias a bodegas de ultracongelación en las regiones del Biobío y Los Lagos.
Las rutas comerciales, en este sentido, confirman estrategias diferenciadas: El 42% del Atlántico tuvo como destino EE. UU., seguido por Brasil y China; en cambio, el 58 % del coho llegó a Japón, mientras Brasil y EE. UU. absorbieron el 12% y 9%, respectivamente. Esta diversificación, recalcan desde el Consejo del Salmón, permite “adaptarse a las preferencias de consumidores en distintas regiones, garantizando salidas comerciales incluso ante contingencias sanitarias o barreras arancelarias imprevistas”.
PERSPECTIVAS 2025
Según el informe del Consejo del Salmón, la leve mejora del tipo de cambio y la normalización de los fletes abren espacio para recuperar márgenes, sin embargo, advierte que la industria enfrentará regulaciones ambientales más estrictas, mayor escrutinio en bienestar animal y una competencia creciente tanto de Noruega como de proyectos de cultivo en tierra (RAS) en EE. UU. y China. Para sostener el liderazgo global, el gremio propone agilizar concesiones marítimas, fortalecer la vigilancia sanitaria -incluidos reportes en tiempo real de patógenos- y acelerar la adopción de sensores remotos y sistemas de alimentación de precisión en las jaulas.
Con respecto a los aranceles impuestos por Estados Unidos en el mes de abril, es importante considerar que ese destino
Enero-Diciembre 2024
Fuente: InfoTrade
RANKING EXPORTADORES CHILENOS DE SALMONÍDEOS
Enero-Diciembre 2024
Fuente: InfoTrade
concentra el 55% del mercado mundial de salmón y recibió el 42% de los envíos chilenos en 2024.
“Estados Unidos es el principal destino del salmón chileno, y su importancia estratégica es indiscutible. En estas primeras semanas tras la implementación del arancel, nos encontramos en un proceso de ajuste y negociación con importadores y supermercados, con una mirada constructiva que busca seguir abasteciendo al mercado estadounidense con un producto valorado por sus consumidores”, explica a Revista AQUA Pablo Barahona.
“Si el arancel del 10% se mantiene o se intensifica, los márgenes de rentabilidad se verán presionados, en especial en productos con mayor procesamiento. La industria está tomando medidas de eficiencia y reformulación logística, pero claramente el escenario óptimo es evitar distorsiones arancelarias en una relación comercial tan integrada”, concluye.
“Si el arancel del 10% se mantiene o se intensifica, los márgenes de rentabilidad se verán presionados, en especial en productos con mayor procesamiento”, advierte Pablo Barahona.


Industria mitilicultora
LA MITILICULTURA CHILENA AFIANZA SU LIDERAZGO MUNDIAL CON 400.000 T DE CHORITOS EN 2024, PERO LA CAÍDA DEL 25% EN CAPTACIÓN DE SEMILLAS, LOS DESAFÍOS AMBIENTALES Y REGULATORIOS PODRÍAN REDUCIR LA PRODUCCIÓN PARA EL PERIODO 2025.
La producción de mitílidos, en especial los choritos (Mytilus chilensis), representa una de las actividades acuícolas más relevantes en Chile, posicionando al país como el segundo productor mundial de mejillones.
Esta industria ha crecido significativamente en las últimas décadas, impulsada por la alta demanda internacional, especialmente en Europa y Asia, la cual ha podido ser satisfecha debido a las condiciones ambientales favorables del sur de Chile. Los mitílidos no solo constituyen una fuente importante de proteínas para el consumo humano, sino que también generan empleo y dinamizan la economía local, particularmente en zonas rurales costeras.
La región de Los Lagos se ha consolidado como el epicentro de la mitilicultura en Chile, con comunas como Puerto Montt, Curaco de Vélez y Calbuco liderando la cosecha y producción de choritos, de acuerdo con el Boletín de Mitílidos elaborado por el Instituto Nacional de Estadísticas (INE).
Este sector no solo es crucial para la economía local, sino
que también enfrenta desafíos cíclicos, como la disminución en la captación de semillas, que se estima podría reducir la producción en alrededor de un 20% para 2025 debido a factores como mareas y corrientes desfavorables.
A pesar de estas fluctuaciones, la industria continúa siendo un motor económico y social en la región, generando empleo y posicionando a Chile como un actor clave en el mercado global de mitílidos.
Al respecto, el director ejecutivo de la Asociación de Mitilicultores de Chile A.G. (AmiChile), Rodrigo Carrasco, detalla que durante el 2024, las cosechas totales de mejillón bordearon las 400.000 toneladas, lo que implica alrededor de un 3% más que lo logrado en 2023, cuando se cosecharon 390.000 toneladas, pero un 5% menos que en años anteriores, como en 2021 y 2022, cuando se lograron volúmenes cercanos a las 420.000 toneladas.
“De lo anterior se desprende que las cosechas totales han tenido una tendencia a disminuir en los últimos años, a lo que se debe agregar el efecto de reducción que tendrán en los años siguientes debido a la menor captación de semilla ocurrida en las últimas temporadas”, asevera Carrasco.
“En términos de exportaciones, durante 2024 se enviaron más de 90.000 toneladas a más de 60 países de destino, y que significaron retornos para el país en torno a los US$320 millones. En los últimos cinco años, los principales mercados compradores han sido España, Rusia, Francia, Italia, Estados Unidos, Tailandia y Reino Unido, los cuales concentran más del

60% de los envíos de mejillones chilenos”, expone el director ejecutivo de AmiChile.
“En 2024 y 2025 enfrentamos una disminución en las captaciones de semillas. Según datos oficiales, las colectas durante el primer semestre de 2024 disminuyeron un 25% respecto del año anterior”, añade Carrasco.
Sobre de las causas específicas que han provocado la menor disponibilidad de semillas, el representante de la asociación de mitilicultores destaca que no existen a la fecha estudios científicos determinantes ni una única respuesta, “pero se puede advertir que la primera etapa de la cadena del mejillón está sometida a factores ambientales cambiantes y cíclicos, que tienen una relativa periodicidad y que, para profundizar en su modelación, se necesita del apoyo de la ciencia y el análisis de datos que nos permitan anticipar de mejor forma las variables y tomar las medidas o definir las estrategias, de manera conjunta con autoridades e investigadores”.
Comenta que es esperable que esta situación de menor disponibilidad de semillas afecte a la baja las cosechas de mejillón para 2025 y 2026.
Sobre cómo han influido el escenario económico global de guerra arancelaria y la falta de ordenamiento en el borde costero durante el periodo, Rodrigo Carrasco sostiene que, “son temas muy distintos entre sí, pero que tienen una afectación directa en las actividades de cultivo de mitílidos, tanto en la producción como en las exportaciones”.
“Si bien Estados Unidos no es nuestro principal mercado de
destino, vemos con preocupación esta situación y estimamos que podría tener algún impacto más allá de dicho mercado, aunque todavía desconocemos la magnitud de los efectos globales de estas alteraciones. No obstante, desde AmiChile estamos trabajando fuertemente en la diversificación de los mercados. Ello nos ha permitido estar presentes y realizar campañas de difusión en países como India, México y China, que tienen un tremendo potencial para nuestro producto”, afirma.
Respecto del ordenamiento en el borde costero, es un tema que los mantiene muy activos y trabajando en distintos frentes. Como se sabe, casi el 100% de su producción se genera en la región de Los Lagos, zona donde no hay disponibilidad de nuevas concesiones y muchas dificultades para, por ejemplo, construir infraestructura de embarque y desembarque.
“Situaciones como la ‘Ley Lafkenche’, y la falta de una política nacional, genera estancamiento e incertidumbre, lo que dificulta el desarrollo y competitividad de nuestra industria. Es por ello que como asociación gremial hemos estado disponibles a participar y colaborar en todas las instancias que apunten a mejoras en este sentido”, comenta el director ejecutivo de AmiChile.
Desde AmiChile están trabajando en distintos temas. Dentro de ellos está el desarrollo de ciencia e investigación aplicada, de forma de lograr mayores certezas respecto de la captación de semillas y cosechas, las variables que le afectan, así como en la disminución de los impactos de la actividad en el medio
“Durante 2024 se enviaron más de 90.000 toneladas a más de 60 países de destino”, director ejecutivo de AmiChile, Rodrigo Carrasco.

ambiente. Como también soluciones concretas del punto de vista medio ambiental, con un Acuerdo de Producción Limpia APL y proyectos de investigación de economía circular.
mos seguros que este tipo de recomendaciones apoyarán en una mayor valoración y consumo de los mejillones chilenos”, expresa.
Así también, el gerente regional de Camanchaca Cultivos Sur, Rafael Ortega, analiza el periodo y cómo el sector mitilicultor aborda la actual temporada productiva.
“En 2024, Camanchaca Cultivos Sur procesó 34.000 toneladas de materia prima de mejillones (choritos), de las cuales un 16% correspondió a compras de terceros. Se transformaron en 6.000 toneladas de carne y 5.000 toneladas de producto entero”, detalla Rafael Ortega.
Añade que, “en cuanto a su desempeño, se mantuvo la escala de producción de mejillones con un aumento en la productividad, manteniendo altos estándares de calidad”.
“Quiero destacar los resultados logrados por las campañas ‘Hay Choritos’ y la marca sectorial desarrollada con ProChile ‘Chile Mussel’”, director ejecutivo de AmiChile, Rodrigo Carrasco.
“Por el lado comercial, continuaremos trabajando para aumentar la demanda del producto tanto a nivel nacional como internacional. En este sentido, quiero destacar los resultados logrados por las campañas ‘Hay Choritos’ y la marca sectorial desarrollada con ProChile, ‘Chile Mussel’, las que están dando positivos resultados de difusión de nuestro producto tanto en Chile como en los mercados internacionales”, enfatiza Carrasco.
“En términos comunitarios, desde AmiChile estamos realizando un fuerte trabajo territorial, tanto para escuchar a todos nuestros socios como para conocer a nuestros vecinos. Muchos de ellos pequeños productores que son socios del gremio, y también con otros gremios de mitilicultores y semilleros con quienes compartimos distintas gobernanzas público-privadas”, revela.
Finalmente, Rodrigo Carraco destaca el reconocimiento que hizo el Seafood Watch, institución dependiente de la ONG Monterrey Bay Aquarium, y que catalogó a los mejillones de cultivo como Super Green, es decir, recomendó su consumo por su valor nutricional y su aporte al medio ambiente. “Esta-
En 2024, las exportaciones de mejillones desde Chile crecieron en US$7 millones respecto de 2023, con un aumento del 3% en el valor de exportación, alcanzando los US$297 millones, según datos de Aduanas. Los principales mercados para los mejillones de Camanchaca fueron Norteamérica, Europa y Asia, distribuyéndose en más de 30 países, detalla el ejecutivo de la compañía.
Explica además, que “durante 2024, el contexto fue desafiante debido a factores ambientales como floraciones algales nocivas (FAN) y cambios en la calidad del agua, que son riesgos reconocidos para la actividad. Sin embargo, mediante iniciativas como el Programa de Sanidad de Moluscos Bivalvos (PSMB) se minimizan estos riesgos. El ciclo productivo siguió basado en la captación natural de larvas en primavera en zonas estuarinas, trasladándose luego a los centros de engorda ubicados en Chiloé”.
Ahora bien, respecto al contexto global, el escenario económico ha afectado especialmente los precios. En 2024, éstos cayeron un 4%, aunque fue compensado por un aumento de volumen del 7% en las ventas.
“Frente a esta dinámica, la Compañía no solo enfrentó los desafíos, sino que también identificó oportunidades, fortaleciendo su red de oficinas comerciales para estar más cerca de
*Fuente: INE Los Lagos - Boletín de Mitílidos en base a datos preliminares de Aduanas.
* Fuente: INE en base a información del Servicio Nacional de Aduanas.
los clientes y adaptarse con mayor agilidad a escenarios de alta volatilidad en los mercados”, afirma el gerente regional de Camanchaca Cultivos Sur.
Adelanta que este 2025, Camanchaca enfocará sus esfuerzos en lograr estabilizar y consolidar sus operaciones en cultivos propios; consolidar una relación de largo plazo con productores artesanales, y fortalecer toda su cadena productiva: proceso, calidad, despachos y desarrollo.
“También hemos puesto el foco en lograr una alta rotación de inventario trabajando bajo una metodología de planificación integral. Además de estrechar relaciones con los clientes para detectar sus necesidades, con un foco especial en el desarrollo de productos de valor agregado, la mejora en los niveles de servicio, el fortalecimiento de los estándares de calidad y diversificación en los mercados internacionales. Con el objetivo de consolidar nuestra posición competitiva”, concluye Rafael Ortega.

*Fuente: InfoTrade. Empresa
“Se mantuvo la escala de producción de mejillones con un aumento en la productividad, manteniendo altos estándares de calidad”, gerente regional de Camanchaca Cultivos Sur, Rafael Ortega.
LA SEGUNDA EDICIÓN DEL FORO REUNIÓ A LÍDERES DE LA INDUSTRIA, AUTORIDADES Y EXPERTOS PARA PROYECTAR EL CRECIMIENTO SOSTENIBLE DEL SECTOR.
La segunda Conferencia AquaForum Aysén 2025, organizada por B2B Media Group e iMercados, se llevó a cabo el 29 de abril pasado, en el Hotel Loberías del Sur de Puerto Chacabuco (región de Aysén), congregando a representantes de la salmonicultura, autoridades regionales, académicos y proveedores.
El evento contó como auspiciadores Diamond a Mowi, InnovaSea, Sudvet, OXZO, Abastible y AbastibleTec; como auspiciador Gold, a Kolff; y, en la categoría de auspiciadores sociales, a Oxysur y AgrupAysén. Además, tuvo el patrocinio de SalmonChile, del Consejo del Salmón, de Corfo, de la Subsecretaría de Pesca y Acuicultura, del Servicio Nacional de Pesca y Acuicultura y del Gobierno Regional de Aysén.
Ante un auditorio completamente lleno, el gerente general de B2B Media Group, Cristián Solís, dio el puntapié inicial, brindando la bienvenida y destacando la relevancia de AquaForum Aysén: “El evento de este año los marcamos dentro de un ámbito de incertidumbre nacional y mundial. El efecto de los aranceles impuestos por Estados Unidos recién empieza a revelarse y eso podría cambiar algunas estrategias comerciales en este mayor mercado que es para la industria sanitaria nacional”. Agregó que “así también la presión regulatoria, conflictos
territoriales y superposición de normativas medioambientales ponen en constante estado de alerta a nuestra industria”.
“Chile necesita una salmonicultura fuerte, transparente y respetuosa de su entorno. La región de Aysén merece una industria que no solo genere empleo e inversión, sino que también se integre de manera virtuosa al tejido social”, expresó el ejecutivo.
A continuación, el director Corporativo y de Compliance del Consejo del Salmón, Rodrigo Pinto, subrayó la magnitud del reto que enfrenta la salmonicultura, expresando que “la industria tendrá capacidad y exigencia de asumir ese desafío. Cada empresa lo está abordando en particular, pero aquí se requiere una alianza público-privada para sacarlos adelante”.
“Los aranceles extranjeros no son controlables por Chile, menos por la industria. Pero sí la regulación interna, el modo de trabajar y la alianza público-privada. Sí son controlables para Chile y los chilenos. Así que es un deber para las autoridades presentes, y con las autoridades me refiero a las de la industria y las del sector público, el conversar y aliarse” continuó, agregando que “conversando sobre una mesa sincera vamos a sacar adelante soluciones paso a paso para una industria que produce el segundo bien más exportado por Chile después del cobre”.
Acto seguido, el presidente de SalmonChile, Arturo Clément, puso foco en las brechas históricas de la región de Aysén, mencionando que es “una región muy extensa y lejana, con brechas estructurales y desafíos que persisten

hasta el día de hoy, como el costo energético, escasez de especialidades en materia de salud, déficit de vivienda y conectividad. Es indudable que la importancia que tiene la salmonicultura para Aysén, y por eso queremos centrarnos en los desafíos y en las oportunidades que tenemos como región y como actividad salmonera”.
Dijo, además, que “acá queremos reconocer el impulso y la valentía que le han dado los parlamentarios y las autoridades regionales, con marcado carácter regionalista, y que han tenido la visión de mirar al litoral como fuente de desarrollo y oportunidades. Este impulso es necesario, potencial y consolidable”.
Por su parte, el delegado Presidencial Regional, Jorge Díaz, destacó que “la conversación franca, no desde la trinchera, la conversación respecto de cuáles son los legítimos intereses que cada sector plantea son la fórmula correcta para poder llegar a acuerdos. Y aquí hay una disposición precisamente para eso, para llegar a los mejores acuerdos que permita en una región como la nuestra, que tiene 120 años menos que nuestros vecinos”.
Por su parte, el gobernador regional, Marcelo Santana, mencionó que “para todos es conocido que este sector ha estado permanentemente torpeado y que, además, se desenvuelve en un marco de incertezas sobre regulaciones que hacen muy difícil avanzar y proyectarse en esta materia. He visto también que en materia legislativa muchas veces se norma sobre una mirada general que no se condice con las
realidades y visiones regionales tan necesarias para construir un proyecto genuino de región”.
Posteriormente se dio paso al primer conversatorio, denominado “¿Hacia dónde va la agenda legislativa de la salmonicultura 2025?”, el cual fue moderado por el Founder & Managing Director de Pluribus Consulting Chile, Francisco Moreno; en el cual participaron el senador David Sandoval; la asesora jurídica de SalmonChile, María Alicia Baltierra; el diputado Miguel Ángel Calisto; el gerente de Asuntos Regulatorios en Australis Seafoods, Mauricio Delgado; y el gerente de Asuntos Corporativos y Sostenibilidad de Multi X, Francisco Lobos.
Durante su intervención, el diputado Calisto dijo que “si el Estado no garantiza certezas jurídicas, no podemos exigir nada. Pero si lo hace, la industria pagará impuestos para que el litoral se desarrolle”, invitó, además, al gobernador regional y a sus pares parlamentarios a “definir una hoja de ruta que responda a las necesidades de Aysén y no a una tendencia política”.
En este sentido, Mauricio Delgado advirtió que la legislación acumulada ha derivado en un verdadero monstruo normativo, difícil de comprender y administrar. Según Delgado: “En el fondo eso es lo que ha ocurrido, y en la medida en que la legislación se ha ido desacoplando de objetivos de nuevos tiempos, por decirlo de alguna manera, hemos estado en una lluvia de proyectos de ley que van esquilmando, van sumando, y al final esta es una quimera súper difícil de comprender y de administrar”.
“Los aranceles extranjeros no son controlables por Chile, menos por la industria. Pero sí la regulación interna, el modo de trabajar y la alianza público-privada”, expresó el director Corporativo y de Compliance del Consejo del Salmón, Rodrigo Pinto.


Der.:
“Es indudable que la importancia que tiene la salmonicultura para Aysén, y por eso queremos centrarnos en los desafíos y en las oportunidades que tenemos como región y como actividad salmonera”, mencionó el presidente de SalmonChile, Arturo Clément.
Francisco Lobos, por su parte, expresó que “sin duda que es necesario avanzar en una política de Estado clara. Es lo que todos anhelamos, es lo que todos esperamos, una política de Estado que sea robusta, que dirija el camino, que ordene este marco regulatorio que todos queremos y que dé seguridad a la inversión”.
Continuó el foro con el Módulo I, denominado “Aysén Energética – un enfoque integral para la inversión y el desarrollo”, el cual, bajo la moderación del consultor y ex seremi de Energía de la región de Aysén, Carlos Díaz; tuvo como invitados a la diputada Marcia Raphael, quien presentó “Aysén y su potencial energético: Clave para un desarrollo sustentable”, mientras que el gerente Comercial de OXZO, Gonzalo Boehmwald, se explayó sobre “Oxymar: Innovación multifuncional al servicio de la eficiencia energética”.
La diputada Marcia Raphael expresó en este módulo que “en energía eólica, la velocidad del viento supera los 14 metros por segundo, el mejor viento del mundo que tenemos en la región de Aysén. Tenemos una extensión de más de 3.000 kilómetros cuadrados para generar energía solar. Nuestro recurso hídrico tiene la capacidad para generar centrales de pasada con 5.259 megawatts, o sea que el 83% del potencial nacional está en la región de Aysén. Y además un potencial geotérmico y capacidad de generación mediante biomasa forestal. Con todo esto, la capacidad de generación de energía en la región de Aysén supera los 13.000 megawatts y, aun así, seguimos teniendo una matriz energética mayor del 52% con producción de combustibles fósiles”.
En este sentido Gonzalo Bohemwald habló de la importancia que OXZO le da a la eficiencia energética de sus productos, expresando que “para nadie es un misterio que los sistemas
de soporte nuestros que generan oxígeno son consumidores de energía, en este caso diésel. Kilowatt más, kilowatt menos, pero debido a la importancia de la solución, sí son una fuente que consume energía eléctrica. ¿Qué es lo que estamos haciendo nosotros como para poder tratar de apoyar y mitigar este consumo? Son varias cosas, lo hemos acordado desde un punto de vista interno, pero también con el apoyo de todos nuestros proveedores. Hoy día lo que les quiero mostrar es de alguna manera una multifunción de una solución que permite abordar distintas problemáticas y problemáticas de los centros de colectivo”.
Agregó que “como pueden ver, nosotros desde hace bastante tiempo definimos como uno de nuestros pilares más relevantes el tema de la eficiencia energética. Por lo tanto, cualquier solución, cualquier desarrollo que se quiera presentar, que se trabaje, tiene que ir enfocado en esa línea. Eso es común y transversal para todas las soluciones, equipos, productos, servicios que tiene la compañía”.
El Módulo II, denominado “Programas de fomento para reactivar la actividad acuícola regional”, tuvo al director Corporativo y de Compliance en Consejo del Salmón, Rodrigo Pinto, como moderador, quien dio paso al tema “Programa territorial integrado para proveedores de la industria del salmón versión 2.0”, expuesto por el director Regional de Corfo Aysén, Humberto Marín; seguido por la directora de Invest Patagonia, María José Urrutia, quien detalló respecto de la “Red de inversión en apoyo a emprendedores para fomentar el desarrollo económico del sur de Chile”.
Posteriormente se dio paso al segundo conversatorio de la jornada, denominado “Iniciativas para activar apoyo a proveedores de la región de Aysén”, el cual fue moderado por el


director regional de Corfo, Humberto Marín, y que tuvo como participantes al jefe de la División Fomento e Industria en el GORE Aysén, Fernando Guzmán; la gerenta de Gestión, Estudios y Proyectos en SalmonChile, Marcela Bravo; el presidente en Corporación de Desarrollo Productivo del Litoral de Aysén (CorpAysén) y director en A.G. de Prestadores de Servicios Acuícolas de Aysén (AgrupAysén), Hernán Rebolledo; el gerente general de Mowi Chile, Fernando Villarroel; y la presidenta de la Asociación Gremial de Proveedores de la Industria Acuícola de Aysén (Acuiprov A.G.), Katia Inostroza.
En sus palabras, Fernando Villarroel expresó que “la salmonicultura no crece sola: crece con sus proveedores y con el territorio”, afirmó, subrayando la importancia de fortalecer las capacidades técnicas y de gestión de los emprendedores y empresas locales.
En su participación, el ejecutivo también abordó el llamado a construir un entorno más favorable para el crecimiento regional, enfatizando la necesidad urgente de avanzar hacia un marco regulatorio claro, eficiente y estable. “Sin certeza jurídica, no hay inversión. Y sin inversión, no hay encadenamientos productivos”, expresó.
El último módulo de la jornada estuvo titulado “Innovación en nutrición: Un pilar de sanidad”, el que tuvo como moderadora a la directora ejecutiva en Center for Antimicrobial Stewardship in Aquaculture (CASA) y directora en Laboratorio de Farmacología Veterinaria (Farmavet) de la Universidad de Chile, Javiera Cornejo; con presentaciones del gerente del PTEC-INVA, Daniel Nieto, quien expuso sobre “PTEC-INVA: Cuatro años uniendo la agricultura con la acuicultura”; el profesor asociado y director académico en Center for Research and Innovation in Aquaculture, Jurij Wacyk, quien dio la charla “Nutrición de Peces: Un
pilar para la sanidad en acuicultura”; y la CEO de Sudvet Corp, Marcela Delgado, quien expuso respecto de la “Transformación Natural: Camino a la Sostenibilidad, optimización del bienestar y productividad”.
Marcela Delgado expresó en sus palabras que el calentamiento global y las nuevas amenazas sanitarias exigen un enfoque más integral que los fármacos convencionales. “Es por ello que también estamos hoy día trabajando para los desafíos ambientales que son el calentamiento global y todo eso que nos compone cada vez en tener más desafíos sanitarios”, comentó la ejecutiva, advirtiendo que, sin ir más lejos, el año pasado hubo 1,5 grados más de temperatura, “lo cual también ha expuesto a los salmones a desafíos más grandes y lo mismo pasa con nosotros, con los humanos, apareciendo nuevas enfermedades que no solamente se deben tratar con fármacos, sino con soluciones más naturales y sustentables. Esta idea es producir productos bajo una agricultura orgánica, trabajar con bienestar animal, desarrollar innovación en términos de sustentabilidad, adaptar los mecanismos acuáticos al cambio climático, disminuyendo el impacto ambiental y no teniendo un impacto en el ecosistema”, dijo.
Por último, el panel “Alimentando el futuro: La sinergia entre la agricultura y la salmonicultura”, estuvo moderado nuevamente por Javiera Cornejo, e intervino el agricultor de la región de Aysén, Joaquín Martínez; el gerente Técnico de Salmones Aysén, David Garrido; y el Head of Technical Department en Aminochem, Carlos Baier.
Para cerrar, Cristián Solís agradeció la participación de todos los actores y resaltó el compromiso de trabajar de manera colaborativa para consolidar una salmonicultura fuerte, innovadora y respetuosa del entorno.
Segundo conversatorio de la jornada.
“He visto también que en materia legislativa muchas veces se norma sobre una mirada general que no se condice con las realidades y visiones regionales tan necesarias para construir un proyecto genuino de región”, dijo el gobernador regional, Marcelo Santana.
DESCUBRE EN ESTA GALERÍA LOS MOMENTOS MÁS
EMBLEMÁTICOS DE LA SEGUNDA EDICIÓN DE AQUAFORUM
AYSÉN: ROSTROS Y SONRISAS QUE REFLEJAN LA CAMARADERÍA Y LA INTEGRACIÓN DE LA SALMONICULTURA PATAGÓNICA.
La segunda edición del foro, organizada por B2B Media Group, se celebró el 29 de abril en el Hotel Loberías del Sur de Puerto Chacabuco y congregó a autoridades, académicos y representantes de toda la cadena de valor para trazar una hoja de ruta hacia un desarrollo sostenible de la salmonicultura en la región. El evento, se estructuró en cinco módulos temáticos que abordaron desde la agenda legislativa para 2025 hasta la integración de energías renovables y la reactivación de proveedores locales. Entre los primeros paneles, expertos como Rodrigo Pinto (Consejo del Salmón) y Arturo Clément (SalmonChile) coincidieron en que solo a través de mesas de diálogo sinceras se podrá conciliar la competitividad con el cuidado del entorno y el bienestar de las comunidades.
La segunda mitad del día profundizó en oportunidades concretas: en “Aysén Energética” se exploraron soluciones de eficiencia y RAS; en el bloque de fomento a proveedores se presentaron programas de Corfo y Invest Patagonia; y finalmente, en el espacio de “Innovación en nutrición” se destacó el rol de la sanidad y la alimentación como ejes de una acuicultura más responsable. El cierre, con el panel “Alimentando el futuro: La sinergia entre agricultura y salmonicultura”, ratificó el compromiso de todos los actores por una industria fuerte, resiliente y respetuosa de su territorio.
Repase los rostros de los protagonistas de la jornada: Políticos, productores, académicos y proveedores, que son quienes dan vida a la industria de la región.



Foto 4: Hernán Rebolledo, Fernando Villarroel, Katia Inostroza, Fernando Guzmán, Marcela Bravo y Humberto Marín.

Foto 5:
Jurij Wacyk, Javiera Cornejo, Marcela Delgado y Daniel Nieto.
Foto 6: Javiera Cornejo, David Garrido, Joaquín Martínez, Carlos Baier.




Foto 9: Cristian Rosales, Marcela Delgado y Leslie Asencio.
Foto 10: Klaus Krinfokai, Ulises González, Franco Medina, Francisco Álvarez, Natalia Segura y Juan González.




Desinfección rápida y natural, eficacia en cada gota.


¿Quieres garantizar la higiene en tu planta de alimentos?
ANOLEX®, máxima eficacia, total seguridad y un compromiso sostenible para liderar el cambio en la industria aquícola.
Desinfección eficiente, eliminando patógenos en solo 30 segundos.




El biofouling en acuicultura afecta negativamente las infraestructuras, reduce el flujo de agua, aumenta el peso de redes y genera riesgos sanitarios. Estos problemas comprometen el bienestar de los peces al deteriorar la calidad del agua, incrementar enfermedades, causar estrés y lesiones, mermando su crecimiento y supervivencia. Las pinturas antifouling de Renner Coatings ofrecen la mayor eficacia contra incrustaciones marinas, manteniendo un desempeño constante durante todo el ciclo productivo. Su formulación permite una lixiviación controlada que garantiza

durabilidad mientras las redes permanecen sumergidas, reduciendo significativamente recambios y limpiezas. Son compatibles con variados materiales de redes de cultivo, sin afectar su flexibilidad ni resistencia.
Como parte de las necesidades operativas de los centros de cultivo, Renner Coatings provee esquemas de productos para boyas de fondeo, pontones y bateas para el traslado de redes, confi-



riéndoles protección de alto desempeño y durabilidad.

Estos productos, ya sea para redes o equipamientos de los centros, destacan por su resistencia al desgaste mecánico, abrasión y acción del agua salina. La línea cumple con normativas nacionales e internacionales sobre uso de sustancias químicas y biocidas, además de cumplir estándares
Tel.: + 56 2 22709000 www.rennercoatings.com
de sustentabilidad ambiental. Son fabricadas en Chile, en una de las plantas industriales más modernas del continente.
Renner Coatings pertenece al grupo Renner Herrmann S.A., fundado en Brasil en 1927, con 98 años de tradición en pinturas y recubrimientos de alto rendimiento. El grupo cuenta con 11 fábricas en tres continentes y opera en 80 países. En Chile está representado por dos plantas: pinturas y revestimientos industriales con Renner Coatings en Pudahuel y pinturas y barnices para madera con Renner Sayerlack en Lampa. La compañía se enfoca en innovación tecnológica, respeto a sus colaboradores y responsabilidad socioambiental. En Chile, sus productos se orientan a minería, industria marina, obras de ingeniería, mantenimiento industrial, protección contra incendios y construcción, desarrollando también soluciones específicas según requerimientos particulares de cada cliente.
POR LA DEMANDA INTERNACIONAL. HOY SE CONSIDERA
QUE EL PRINCIPAL DESAFÍO DEL SECTOR ES GARANTIZAR SU SOSTENIBILIDAD Y UN MANEJO ADECUADO DE LOS RECURSOS.
La extracción de algas en Chile se encuentra en un período crucial, con una mayor demanda global y un mercado local en crecimiento. Sin embargo, enfrenta desafíos como las regulaciones ambientales más estrictas y la necesidad de adoptar prácticas más sostenibles.
Desde el punto de vista biológico, las algas comprenden una gran variedad de organismos, que van desde células individuales hasta organismos multicelulares. Según el Laboratorio de Estudios Algales de la Universidad de Concepción, estas se dividen en dos grandes grupos: Microalgas y macroalgas.
El cultivo de macroalgas en el país comenzó en la década de 1980 y ha sido desarrollado principalmente por pescadores artesanales, especialmente en la región de Los Lagos, según investigadores de la Universidad Austral de Chile. Aunque se trata de una actividad de pequeña escala, ha logrado mantenerse activa durante décadas.
En conversación con Revista AQUA, el Servicio Nacional de Pesca y Acuicultura (Sernapesca) comparte su visión sobre las cifras actuales de exportación de algas chilenas y sus principales mercados.
Desde el organismo fiscalizador, explican que durante el período 2020-2024, se exportaron anualmente 17 especies de algas. “Huiro negro o chascón es el 58,4% del total durante ese lapso, siendo enviado principalmente en seco y no para consumo humano”, agregan. (Ver gráfico 2).
Detallan, además, que en cuanto a los principales mercados de destino, se realizaron exportaciones a 82 países en este periodo, siendo los principales China, Japón, Francia, Noruega y Dinamarca. “Entre estos cinco mercados se encuentra el 87,2% de las exportaciones, siendo China el más importante, con el 72,7% del total”, expresaron. (Ver gráfico 3).
Consultados por Revista AQUA, el Instituto de Fomento Pesquero (IFOP) destaca su rol fundamental en la gestión sostenible de las pesquerías de algas en Chile.
Desde el organismo explican que, en el ámbito de las pesquerías de macroalgas en Chile, Ifop cumple el rol de asesor del administrador pesquero de la Subsecretaría de Pesca y Acuicultura, para la toma de decisiones en la gestión sostenible de estos recursos. “La entrega de insumos al Comité Científico Técnico Bentónico para la evaluación del estatus y cuotas de extracción en las pesquerías con esa herramienta de manejo”, agrega.
En ese sentido, la asesoría se realiza a través de estudios de investigación pesquera, principalmente de la cartera de investigación permanente en convenio con el Ministerio de

Economía y de estudios concursables de Fondo de Investigación Pesquera.
“Se realizaron exportaciones a 82 países durante el periodo 2020-2024”, afirma el Servicio
Nacional de Pesca y Acuicultura.
En cuanto a los estudios que realiza el IFOP sobre la extracción de algas y su sostenibilidad en las zonas costeras del país, agregan que a pesar de la larga data de la extracción de macroalgas en Chile y su relevancia en la última década, la investigación científica nacional ha estado centrada mayormente en aspectos ecológicos, de cultivos y otros.
“No directamente vinculados a la urgencia del manejo de las praderas naturales en el extenso litoral en el que se desarrollan estas pesquerías, con una importante participación de actividad informal en un escenario en que Chile es el mayor aportante de insumos de origen natural en un mercado dominado por el aporte de la acuicultura”, explican.
En ese contexto, desde el organismo expresan que la orientación de la asesoría de IFOP se ha dirigido a salvar esa brecha, a través de estudios de campo continuos, consistentes en monitoreos poblacionales in situ, de temporalidad anual para las especies de Lessonia sp. “y estacional para Macrocystis sp., en el contexto de los Planes de Manejo Bentónicos, implementando métodos de evaluación de pesquerías pobres en datos para un pronunciamiento del estado de las praderas en escala local”, aseveran.
Además, se desarrollan experimentos de campo en la región de Atacama para describir parámetros del ciclo de vida, que permitan implementar modelos de dinámica poblacional de mayor complejidad.
En el contexto de la orientación del manejo tradicional de las llamadas pesquerías de pequeña escala, basado en indicadores, hacia un manejo basado en puntos de referencia, se han propuesto y se trabaja en la implementación de puntos de referencia empíricos, para la administración en Planes de Manejo y las decisiones cuotas.
“En forma complementaria, se elabora una propuesta de administración integral para estas pesquerías, independiente de los regímenes de manejo, como Planes de Manejo Bentónicos, Amerb y otros”, mencionan.
En cuanto a cómo contribuye IFOP a la gestión y regulación de la extracción de algas en Chile a través de sus investigaciones, comentan que su labor es ofrecer, en forma inédita, puntos de referencia del nivel de sostenibilidad de las praderas al Comité Científico Bentónico, de forma de evaluar las cuotas de extracción en las regiones en las cuales existen Planes de Manejo Bentónicos con esta medida de regulación pesquera.
Respecto a las proyecciones o tendencias identificadas por Ifop sobre el futuro de la extracción de algas en Chile, explican que, en el marco de la denominada “Ley Bentónica”, aprobada en 2024 como parte de la actual Ley de Pesca, se establece la posibilidad de establecer puntos de referencia para el manejo de las praderas naturales (en el contexto de los recursos bentónicos en general), alternativos al MRS (Máximo Rendimiento Sostenible).
“En distintas escalas espaciales, de naturaleza empírica, que basadas en la ciencia pesquera, permita incrementar el
Fuente: Sernapesca
implementar el manejo de estos recursos que poseen dinámicas y son afectados en forma local”, aseguran.
“Lo anterior en línea con la estrategia de la asesoría abordada por IFOP previamente, que requiere implementar en el futuro programas de monitoreo directo (evaluaciones directas) e indirecto (desembarques)”, detallan.
En ese contexto, el requerimiento de implementación de la Ley, en el futuro, debería permitir incrementar la cobertura geográfica de zonas con explotación de macroalgas con algún régimen de administración.
“Dada la naturaleza nacional de estos, están orientadas al comanejo (Estado – usuarios) para implementar desde esa plataforma un manejo y administración con enfoque ecosistémico, complementando la gestión de pesquerías con otros ámbitos de investigación”, agregan.
Finalmente, desde IFOP aseguran que el incremento de la investigación, como un requerimiento para el manejo futuro y la implementación de un enfoque ecosistémico, permitirá el
desarrollo de modelos de mayor complejidad para un manejo con menores incertidumbres.
La extracción de algas en Chile ha crecido en los últimos años, impulsada por la demanda internacional. Sin embargo, este desarrollo plantea desafíos como la pesca ilegal y la necesidad de fortalecer la sostenibilidad de los recursos y la actividad económica. La Dra. Fadia Tala, académica de la Universidad Católica del Norte, e investigadora del Centro de Investigación y Desarrollo Tecnológico en Algas y otros Recursos Biológicos (CIDTA) y del Instituto Milenio en Socio-ecología Costera (SECOS), analiza el escenario actual y los desafíos que enfrenta el sector.
La académica expresa que es una actividad que ha ido incrementando en los últimos años en cuanto a los volúmenes que se extraen, pero con ciertas fluctuaciones. Esto está condicionado, “principalmente, por la demanda que hay de “Debería permitir incrementar la cobertura geográfica de zonas con explotación de macroalgas”, expresa el Instituto de Fomento Pesquero.
*Algas mixtas corresponden a mezcla de algas usadas para la producción de derivados de algas, como carrageninas o alginatos.
Fuente: Sernapesca




PRINCIPALES MERCADOS DE DESTINO DE ALGAS PERIODO 2020-2024
“Es una actividad que ha ido incrementando en los últimos años en cuanto a los volúmenes que se extraen”, comenta la Dra. Fadia Tala, académica Universidad Católica de Norte. los mercados, porque casi todos nuestros recursos algales se van a exportación”.
“Una parte se procesa en el país, pero los grandes volúmenes, que corresponden a las algas pardas, casi siempre se exportan como materia prima seca-picada”. Entonces, cuando los mercados externos que usan estas algas para producir extractos como alginato, su principal ficocoloide, aumentan su explotación, y crece la demanda de biomasa”, agrega.
La Dra. Tala expresa que esto también tiene su ciclo, ya que, dependiendo del precio del dolar, y por ende del precio de venta de las algas, a veces hay más presión sobre la extracción y otras veces menos.
“Lo cierto es que, en paralelo, se han ido instaurando medidas de administración para la explotación de algas, las cuales provienen de la autoridad pesquera y acuícola correspondiente a la Subsecretaría de Pesca y Acuicultura”, añade.
La doctora es enfática en mencionar que no es que no se
haga nada; en realidad, existen acciones orientadas a asegurar que la actividad sea sostenible y a controlar los niveles de explotación. Sin embargo, como las denuncias de pesca ilegal, que son casi inevitables.
“Dependiendo de las regiones, a veces se establecen cuotasy períodos de veda en áreas de libre acceso. Cuando se extraen algas de áreas de manejo, existe un plan específico para regular la actividad”, afirma.
La académica de la UCN detalla que “hay desafíos en varios niveles. Uno de ellos es cómo evaluar si las medidas de manejo que impone la autoridad realmente funcionan. Es importante saber si estas acciones están cumpliendo su objetivo principal: que las poblaciones se mantengan en el tiempo de forma sostenible. Para eso, se necesita hacer un plan de seguimiento a largo plazo considerando las particularidades de las especies y de las zonas geográficas del país”.
EXPORTACIONES SECTOR EXTRACTIVO Y SECTOR ACUÍCOLA POR LÍNEA DE PRODUCTO A DICIEMBRE 2023-2024
Fuente: Informe Sectorial de Pesca
“La sustentabilidad no es una opción, es parte
competitividad”
EN ENTREVISTA CON REVISTA AQUA, EL PRESIDENTE DE SALMONCHILE, ARTURO CLÉMENT, DESGRANA LA ESTRATEGIA
PÚBLICO-PRIVADA QUE DEBE TOMAR EL PAÍS PARA CUIDAR LOS
86.000 EMPLEOS QUE BRINDA LA INDUSTRIA, ELIMINAR “ARANCELES
INVISIBLES” Y PROYECTAR UN CRECIMIENTO SOSTENIBLE PARA LA SALMONICULTURA CHILENA.
Asiete semanas de la entrada en vigor del arancel base de 10% que la administración de Donald Trump impuso el 5 de abril a la mayoría de los productos industriales y agro-alimentarios chilenos, la salmonicultura lidia con un recargo que podría restar una importante cantidad de millones anuales a las exportaciones y poner en riesgo el futuro de la actividad.
La medida llega en un momento de márgenes ajustados y mercados exigentes, obligando a Chile a desplegar su mejor diplomacia comercial para proteger la segunda industria exportadora de alimentos del país.
Uno de los principales rostros de esa ofensiva es el presidente de SalmonChile, Arturo Clément: Ingeniero de profesión, ha sido testigo de la expansión que convirtió al salmón en el segundo producto de exportación, con ventas por US$2.613 millones en 2024 hacia Estados Unidos.
Para Clément, el desafío no es sectorial, sino nacional: El Ejecutivo debe presentar antes del 12 de junio una propuesta convincente que demuestre a Washington la seriedad con que Chile protege la propiedad intelectual, refuerza la cooperación en patentes y preserva un tratado de libre comercio que ya superó dos décadas.
La magnitud del impacto no se limita a números macroeconómicos. En ciudades como Quellón, Puerto Aysén o Porvenir, el sobrecosto aduanero se percibe en las plantas de proceso: Turnos reducidos y reticencia a nuevas inversiones en plantas de valor agregado. Son señales tempranas de que la decisión de la Casa Blanca no solo tensiona la balanza comercial, sino también la cohesión social de territorios donde el salmón genera hasta el 60% de los ingresos familiares.
Para construir la respuesta, Clément propone un “dream team” negociador que reúna a los ministerios de Hacienda, Relaciones Exteriores, Economía, Agricultura y Ciencia junto con especialistas privados. El objetivo es articular un mensaje único y robusto, evitar improvisaciones y demostrar que la salmonicultura opera con los más altos estándares sanitarios y ambientales del hemisferio sur -un planteamiento que el gremio expuso recientemente ante la Comisión de Economía de la Cámara de Diputados y en reuniones con el ministro Mario Marcel y el canciller Alberto van Klaveren-.
Mientras el reloj avanza, Clément integró la delegación
Fotografía: B2B Media Group

empresarial que acompañó al Presidente Gabriel Boric en la primera visita de Estado a Brasil con motivo del Día de la Amistad entre ambas naciones. Allí se reunió con autoridades del Ministerio de Agricultura, la Confederación Nacional Agropecuaria y operadores del centro mayorista Ceasa, uno de los nodos logísticos clave de São Paulo. Brasil es ya el tercer mercado para el salmón chileno: En 2024 importó 146. 597 t por US$915 millones.
Esa gira presidencial refrendó la estrategia de abrir puertas en paralelo al frente arancelario. Clément subraya que Chile ya despacha productos a más de 100 países, aunque reconoce que crecimientos sustantivos en India, Emiratos Árabes o el Sudeste Asiático demandarán infraestructura, acuerdos sanitarios y educación del consumidor. De ahí la urgencia de resolver la crisis con Washington sin descuidar la competitividad interna: Simplificar trámites, alinear fiscalizaciones y eliminar los llamados “aranceles invisibles” que restan eficiencia incluso sin gravamen aduanero. En entrevista con Revista AQUA, el timonel desgrana la anatomía de lo que ha sido denominado como una “tormenta perfecta” que enfrenta el sector -aranceles externos, burocracia interna y exigencias reputacionales-, defendiendo la idea de un país unido tras un mismo mensaje y proyectando un crecimiento sostenible hacia 2030 gracias a la innovación sanitaria y la mejora continua en bienestar animal.
El 5 de abril entró en vigor un arancel base del 10 % a las exportaciones hacia EE. UU., ¿qué estrategia diplomática y comercial se ha impulsado desde el gobierno y SalmonChile ante Washington para buscar la exención de esta medida?
Estamos colaborando con el Gobierno para establecer una estrategia país que aborde este desafío. No es un tema sectorial, es un desafío que requiere unidad nacional. Proponemos conformar un equipo negociador de excelencia que combine lo mejor del sector público y privado -un dream team- para presentar una posición sólida ante Estados Unidos.
El Gobierno chileno debe presentar una propuesta concreta antes del 12 de junio. ¿Qué rol cumplirá SalmonChile en la preparación y defensa de dicha propuesta?
Nuestro sector está aportando toda su experiencia técnica y conocimiento del mercado estadounidense. Así lo hemos hecho de cara a las reuniones con autoridades como el ministro Marcel, o en la exposición en la Comisión de Economía donde asistió el canciller Van Klaveren. No se trata de apresurarse, sino de construir una propuesta robusta que aborde los temas planteados por Estados Unidos y demuestre nuestro compromiso con una relación comercial de largo plazo.
El cobre está exento, por ahora, de los aranceles. ¿Debiera el gobierno darle prioridad a la industria salmonicultora o, al menos, una importancia similar?
No es tema de prioridades entre sectores. Chile necesita una estrategia integral para proteger su competitividad. El salmón representa el segundo producto más exportado a Estados Unidos, con US$2.578 millones anuales. El potencial impacto económico y social para este sector amerita una atención significativa.
“Estamos colaborando con el gobierno para establecer una estrategia país que aborde este desafío”.
Al respecto de este tema, en entrevista con El Mercurio, usted habló de los “aranceles invisibles”. ¿Cómo inciden estas barreras internas en la competitividad de la salmonicultura chilena y qué iniciativas se deben tomar para reducirlas?
Así es. Tenemos un doble desafío: El arancel externo y los ‘aranceles invisibles’ internos -trabas regulatorias y problemas de permisología- que afectan nuestra competitividad. Con voluntad política, podemos resolver varios de estos obstáculos sin necesidad de cambios legales.
En este sentido, se ha hablado de una “tormenta perfecta” en la industria, pues los desafíos se acumulan, tanto en lo externo, como en lo interno. ¿Ud. concuerda?
Más que tormenta perfecta, prefiero hablar de desafíos y oportunidades. Nuestro sector tiene experiencia en adaptarse. El foco debe estar en mejorar nuestra competitividad como país.
“Tenemos un doble desafío: El arancel externo y los ‘aranceles invisibles’ internos -trabas regulatorias y problemas de permisología que afectan nuestra competitividad-”.
¿Qué estrategias están impulsando los socios de SalmonChile con importadores y grandes cadenas para reconquistar la preferencia del consumidor final en EE. UU.?
Mantenemos un diálogo constante con retail, foodservice y distribuidores en EE. UU. La realidad es que el mercado estadounidense está complejo y es difícil traspasar el arancel al consumidor final. Por eso necesitamos ser más competitivos que nunca y trabajar en conjunto con nuestros socios comerciales para mantener el posicionamiento del salmón chileno.
¿Cómo evalúa la solidez del TLC Chile - EE. UU. tras este episodio y qué ajustes considera que deberán ser considerados a futuro para reforzarlo?
Este episodio demuestra que debemos fortalecer constantemente nuestras relaciones comerciales. Chile debe abordar los puntos señalados por EE. UU., especialmente en propiedad industrial y patentes. Es una oportunidad para modernizar y profundizar nuestra relación comercial.
Hoy se exporta poco más de un 5% del salmón producido a China. ¿Cree que la reactivación de este



mercado post pandemia y la generación de otros mercados puedan crear una diversificación que evite la dependencia de un único gran mercado?
Hemos logrado llegar a más de 100 países, lo que demuestra nuestra capacidad de diversificación. Sin embargo, desarrollar mercados toma tiempo. Mercados como India representan oportunidades interesantes, pero requieren desarrollo de infraestructura y hábitos de consumo. Estados Unidos seguirá siendo estratégico para nosotros
¿Cómo califica hoy la relación del sector con el gobierno y cómo esperan que se transforme?
Como hemos dicho en muchas oportunidades, nuestro sector ha estado siempre disponible al diálogo con el gobierno. En los últimos meses hemos visto un acercamiento, lo que es positivo.
Y en el contexto de los aranceles impuestos por Estados Unidos, valoramos el diálogo establecido y la comprensión de que este es un desafío país. Lo que proponemos es fortalecer esta alianza público-privada para abordar tanto el tema arancelario como los “aranceles invisibles” que afectan nuestra competitividad






Considerando este nuevo desafío, ¿qué horizonte de crecimiento proyecta para la producción chilena de salmón al 2030 y qué cambios estructurales serían necesarios para empujar las proyecciones?
El potencial es significativo, pero necesitamos certeza regulatoria y competitividad. Mientras Noruega planea quintuplicar su producción al 2050, nosotros necesitamos condiciones que nos permitan mantener nuestra posición global. El crecimiento debe ser sustentable y basado en innovación. Porque, como sector productivo, estamos convencidos de que el desarrollo económico, el cuidado del medio ambiente y el derecho de las personas del sur de Chile a prosperar son compatibles.
El sector ha avanzado en reducir el uso de antibióticos y antiparasitarios y en la reducción de su impacto en la producción. ¿Cómo proyecta que estos hitos sanitarios y ambientales refuercen la competitividad global del salmón chileno?
La sustentabilidad no es una opción, es parte integral de nuestra competitividad. Tenemos el 100% de nuestra biomasa certificada internacionalmente por distintos estándares y somos el sector más fiscalizado por la SMA, con un 99,8% de cumplimiento en 2024. Estos no son solo números, reflejan nuestro compromiso con una producción responsable.
Finalmente, ¿qué reflexiones le deja sus años de trabajo en la industria, como de líder gremial, en vista de los diversos desafíos que ha debido enfrentar, tanto

legislativos, como reputacionales? ¿En qué pie debiese estar hoy la salmonicultura en el país?
La salmonicultura representa una historia de éxito en descentralización, movilidad social y desarrollo regional. Generamos 86.000 empleos de calidad y oportunidades para 4.000 pymes en el sur de Chile. El desafío actual requiere unidad nacional y una alianza público-privada renovada. No necesitamos más diagnósticos, necesitamos acción coordinada para fortalecer nuestra competitividad como país.

“Como sector productivo, estamos convencidos de que el desarrollo económico, el cuidado del medio ambiente y el derecho de las personas del sur de Chile a prosperar son compatibles”.
“El consumidor estadounidense tendrá que pagar
EL CONSULTOR DE DNB BANK, EL MAYOR GRUPO FINANCIERO
DE NORUEGA, CONVERSA CON REVISTA AQUA RESPECTO DE LOS
ALCANCES DE LOS ARANCELES ESTADOUNIDENSES PARA LOS PAÍSES PRODUCTORES DE SALMÓN.
La guerra arancelaria que sacude el comercio global ha puesto al salmón chileno en el centro de un tablero impredecible: Desde el 5 de abril, un gravamen base de 10% amenaza con encarecer la proteína estrella de la macrozona sur en su principal mercado, Estados Unidos.
Mientras productores y autoridades buscan un “dream team” negociador que convenza a Washington de eximir al país antes del 12 de junio, se hacen numerosos análisis sobre tema, siendo uno de ellos los bancos.
Dag Sletmo, consultor del DNB Bank y referente internacional en los mercados de productos del mar, conversa con Revista AQUA, desgranando los posibles efectos visibles e invisibles del arancel: La ventaja de Canadá —único gran proveedor libre de gravamen—, la ligera desventaja de Noruega con su prórroga de 90 días al 10% y la mayor exposición de Chile a un mercado que puede enfriarse si la guerra comercial dispara la inflación y deprime al dólar.
El analista evalúa también la capacidad del retail para
absorber sobreprecios, la viabilidad de acelerar proyectos RAS en EE. UU. y los márgenes de maniobra que ofrece la diversificación de mercados.
¿Cuál es el alcance de los aranceles estadounidenses a la importación, en particular sobre los productos del mar, y cómo han cambiado desde su imposición, si es que han cambiado?
Los aranceles son amplios, afectan a todos los países y a todo tipo de productos, incluidos los productos del mar. Y los aranceles propuestos cambian y pueden volver a cambiar. En el caso del salmón, todos los exportadores a EE. UU. se enfrentan a un arancel del 10%, excepto Canadá, que no se enfrenta a tal arancel. Y la tasa del 10% de Noruega forma parte de la prórroga de 90 días anunciada por Donald Trump el 9 de abril. El arancel original de Estados Unidos sobre el salmón noruego fue del 15%, por lo que puede volver (o ser algún otro número).
¿Cómo valora el impacto de estos aranceles en la competitividad de los principales países exportadores de productos del mar a EE. UU.?
Asia es la más afectada, por ahora. No exportan salmón, pero los efectos de sustitución podrían beneficiar al salmón, ya que otras categorías de productos del mar de otras partes
Fotografía: Dag Sletmo

del mundo se ven más afectadas. Si nos fijamos únicamente en el salmón, es evidente que Canadá es el mejor situado, ya que no tiene aranceles. Noruega está en ligera desventaja, con un 15% (pero un 10% durante la prórroga de 90 días), y el resto, con un 10%. Si el mercado estadounidense en general se ve afectado negativamente, Chile podría estar en desventaja relativa en comparación con los productores europeos, ya que Chile depende más del mercado estadounidense.
¿Cómo espera que evolucione la demanda de productos del mar en el mercado estadounidense?
Es muy difícil de predecir. Vemos que los consumidores de EE. UU. en general son cautos, pues temen que las guerras comerciales disparen la inflación. Las guerras comerciales también podrían desencadenar una recesión en EE. UU., lo que sería negativo para la demanda. Ese impacto podría ser mayor que el impacto directo de los aranceles.
Y los productos del mar serán más caros para el consumidor estadounidense, ya que creemos que los productores conseguirán en gran medida trasladar los aranceles a sus clientes, lo que significa que al final pagará el consumidor. Pero por ahora la venta al por menor en EE. UU. tiene márgenes lo suficientemente altos como para absorber el arancel, lo que podrían hacer durante un tiempo.
El salmón es una de las proteínas marinas más importantes que Chile exporta a EE. UU., ¿cómo espera que se vean afectados los volúmenes y los precios?
En igualdad de condiciones, tendrá un efecto negativo en los volúmenes y puede que en los precios. Pero el efecto de los aranceles por sí solos es limitado. Pero una recesión podría reforzar la evolución negativa. Y no hay que olvidar que la actual política de EE. UU. también ha provocado una caída del valor del dólar, lo que encarece los productos importados, como el salmón, para el consumidor. Para Noruega ese impacto es casi tan grande como el propio arancel. Una cuestión macroeconómica clave es si se trata de una volatilidad a corto plazo o del inicio de una tendencia a largo plazo de debilitamiento del dólar.
¿Prevé un aumento de la inversión en proyectos de acuicultura terrestre (RAS) en suelo estadounidense en respuesta a la volatilidad de los aranceles?
Eso podría ocurrir en algún momento, pero pasará mucho tiempo antes de que lo sepamos. La volatilidad arancelaria dificulta todo tipo de decisiones de inversión. Incluso si la producción nacional como tal se vuelve más atractiva, puede que no sea así si se depende de una larga cadena de suministro internacional. Y los aranceles podrían desaparecer mañana, nunca se sabe. O quizá Trump se aferre a ‘sus armas’, pero un nuevo presidente dentro de cuatro años los elimine. Si decides empezar a construir una instalación RAS hoy, no estará lista para producir durante este mandato presidencial. Conseguir permisos y construir lleva demasiado tiempo.
En términos de países productores, ¿qué resistencia cree que tiene la industria noruega a un aumento del 15% de los aranceles?
“En el caso del salmón, todos los exportadores a EE. UU. se enfrentan a un arancel del 10%, excepto Canadá”
Es negativo, por supuesto. Pero no cambia las reglas del juego. El consumidor estadounidense tendrá que pagar los aranceles de Noruega, Chile y los demás productores de salmón. ¿Por qué? Estados Unidos no puede aumentar su propia producción de salmón para sustituir las importaciones. Esto es muy diferente de lo que ocurre con los vehículos, por ejemplo, donde Estados Unidos sí puede hacerlo. En ese caso, los fabricantes de automóviles extranjeros tendrán que absorber más aranceles.
Pero esto significa que el salmón se encarece, y entonces la gente comprará menos. Dado que EE. UU. es el mayor mercado de salmón (alrededor del 25%), tendrá un impacto negativo en el precio del salmón a nivel mundial. Pero no tan grande: Quizá un 2-3%.
¿Qué ventajas competitivas tienen los productores noruegos sobre sus homólogos chilenos, canadienses y escoceses para absorber o trasladar estos costos?

El experto advierte que una recesión puede afectar al consumo del salmón chileno en EE. UU.
“Noruega y los demás productores europeos tienen la ventaja de depender menos de Estados Unidos y de tener más mercados finales a los que vender”.
Noruega y los demás productores europeos tienen la ventaja de depender menos de Estados Unidos y de tener más mercados finales a los que vender. Eso les da más flexibilidad y también más poder de negociación frente a los compradores estadounidenses.
¿Cómo valora el impacto de estos aranceles en los contratos a largo plazo que Noruega tiene con las principales cadenas de EE. UU.?
No creemos que esto tenga un impacto importante a largo plazo, siempre y cuando los aranceles no aumenten significativamente con respecto a los niveles actuales. Reduce ligeramente la demanda, pero el crecimiento subyacente se mantendrá presumiblemente sin grandes cambios.
¿Cómo valora la capacidad de la industria chilena del salmón para adaptarse a estos aranceles en comparación con Noruega?
Creo que la industria del salmón, tanto en Chile como en Noruega, es bastante ágil y buena para gestionar problemas imprevistos y crisis repentinas, y que también se adaptará esta vez.
¿Cuáles son los puntos fuertes y débiles de los productores chilenos a la hora de negociar precios y contratos con los importadores estadounidenses en comparación con los productores noruegos?
El principal punto débil es que dependen más del mercado estadounidense. También solía haber demasiados vendedores chilenos, por lo que los compradores estadounidenses podían enfrentarlos entre sí. Pero eso ha mejorado en los últimos años.
¿Cómo han reaccionado los bancos y las instituciones financieras, incluido el DNB, para apoyar a sus clientes salmonicultores en este escenario?
El experto indica que se prevé un crecimiento alto del volumen de producción de salmón.

Apoyamos a nuestros clientes si es necesario cuando suceden estas cosas. Pero hasta ahora no ha sido un problema relacionado con las tarifas.
¿Cuál es su previsión para el mercado de los productos del mar en lo que queda de año?
La alimentación, incluidos los productos del mar, es en general sólida. La gente necesita comer tanto en los malos como en los buenos tiempos. El factor más incierto es lo que ocurra con el crecimiento económico en Estados Unidos, y en algunas otras partes del mundo, como consecuencia de las guerras comerciales.
Las recesiones nunca son buenas, pero muchos productos del mar son a prueba de recesiones, quizá especialmente el pescado pelágico, pero también el salmón. Los productos vulnerables suelen ser los de gama alta, destinados a unos pocos mercados de nicho.
En cuanto al salmón, este año se prevé un crecimiento del volumen relativamente alto, lo que ejerce cierta presión sobre los precios. Pero el factor clave es la mejora de la biología, que es positiva. Y creemos que el alto crecimiento no continuará en 2026.
Salmonicultura en Chile
En una sesión especial de la Comisión de Economía de la Cámara de Diputados, en la cual también estuvo presente el ministro de Relaciones Exteriores, Alberto van Klaveren, el diputado Mauro González se pronunció con gran preocupación por la crisis que atraviesa la industria salmonicultora en el país.
Durante su intervención, González enfatizó que la combinación de incertidumbres, tanto global como local, ha generado lo que él describe como una “tormenta perfecta”
que podría frenar el desarrollo laboral, social e industrial en esta vital actividad.
El parlamentario destacó cómo la industria del salmón se encuentra bajo amenaza no solo por factores internacionales, sino también por múltiples desafíos internos que afectan directamente a la región de Los Lagos y a toda la zona sur austral de Chile.
“Hoy día tenemos una incertidumbre internacional, pero también una incertidumbre nacional”, afirmó el diputado, subrayando que se requiere una acción inmediata y coordinada por parte del Gobierno para abordar esta crisis.

Durante su discurso, González abordó las preocupaciones relacionadas con el Servicio de Biodiversidad y Áreas Protegidas (SBAP), señalando
El parlamentario destacó cómo la industria se encuentra bajo amenaza no solo por factores internacionales.
• Senado da luz verde a histórica reforma pesquera: Fraccionamiento avanza al tercer trámite
• Carlos Sandoval de VeHiCe: “La mayor problemática son los desarrollos de compresión y fusión”
• AgrupAysén se une a AquaForum 2025 para potenciar el crecimiento regional
• El futuro de la salud acuícola se reúne en encuentro internacional de VeHiCe
• Medidas de bioseguridad: Claves en la calidad del producto acuícola
• Región de Aysén: Fiscalizan estándares internacionales para exportación en plantas procesadoras
que la implementación de reglamentos poco claros pone en riesgo el desarrollo de la industria. Del mismo modo, hizo un llamado a prestar atención a otras iniciativas legislativas que afectan el sector, como la ley Lafkenche y la incierta legislación futura sobre acuicultura, que han contribuido a crear un ambiente de desconfianza entre los actores de la industria.
“Agua Viva”
En un evento que congregó a autoridades, expertos y público general, se exhibió un adelanto de la serie compuesta por ocho capítulos, que abordarán diversas especies cultivadas en Chile como la ostra chilena, el turbot, el chorito, los esturiones y el pelillo, así como un análisis detallado sobre la industria del salmón en tres partes: Su ciclo productivo, aspectos sanitarios y medioambientales, y su futuro. El alcalde de Puerto Montt, Rodrigo Wainraihgt, destacó la importancia de esta industria para la región y la necesidad de proyectarla hacia el futuro de manera sostenible: “En Puerto Montt, capital regional, la industria cumple un rol importante. Genera 40.000 empleos de manera directa y otros 40.000 indirectos, además de aportar significativamente a la micro, pequeña y mediana empresa. Lo importante es que crezcamos de manera sostenible, generando más empleo y recursos para nuestra comuna y región”.
Por su parte, el periodista de Ciencia y Tecnología

de Mega, Daniel Silva, resaltó el aporte del documental como plataforma para un debate más informado: “Un programa como Agua Viva es un tremendo aporte y es súper necesario. Si bien van a haber algunos que siempre van a atacar, otros dirán: ‘Agradezco conocer esto’. Porque detrás de esta gran industria hay familias, tecnología y ganas de mitigar el impacto ambiental con nuevos desarrollos”. Finalmente, el director y conductor de la serie, Tomás Vigneaux, destacó en la importancia de mostrar la acuicultura chilena al país y despertar el interés de nuevas generaciones: “Lo que yo espero con esta serie es que más gente ame la acuicultura, ame el océano, su flora y su fauna”.
En un evento que congregó a autoridades, expertos y público general, se exhibió un adelanto de la serie compuesta por ocho capítulos.































Inscripción gratuita en: >> www.aqua.cl/newsletter <<










AQUA 273 050.indd 1 VÁLVULA
















Nueva gerencia general

La empresa informó que se implementarán cambios en la administración de Yadran. Tras más de diez años al frente de la compañía, Benjamín Holmes dejó el cargo por motivos personales.
Desde la empresa se valoró su gestión, destacando el sello de su liderazgo: “Agradecemos profundamente el compromiso y profesionalismo con los que Benjamín ha guiado nuestra organización durante todos estos años. Su gestión ha estado marcada por importantes avances y desafíos, dejando una huella significativa en la cultura corporativa de Yadran y consolidando la sostenibilidad como una hoja
Ante barreras comerciales
La empresa valoró su gestión, destacando el sello de su liderazgo.
de ruta clave para el desarrollo futuro de la compañía”. En su lugar asumirá Vicente Swinburn, ejecutivo con más de 13 años de trayectoria como gerente comercial en Yadran. Cuenta con un profundo conocimiento del negocio y la industria, habiéndose desempeñado previamente como gerente de Farming en El Golfo (hoy Blumar) y como subgerente de producción en Ventisqueros.
“Asumo la Gerencia General de Yadran con un profundo sentido de responsabilidad y optimismo. Mi gestión se enfocará en seguir optimizado nuestro proceso productivo, honrando siempre la reputación de calidad y excelencia que nos distingue. Confío plenamente en que la dedicación, experiencia y pasión de cada uno de nuestros colaboradores serán los pilares esenciales para alcanzar nuestros
• ¿Cómo destrabar el tema de los aranceles para el salmón?: “La llave está al interior Chile”
• Mowi se incorpora como Auspiciador Diamond en AquaForum Aysén 2025
• Ante un auditorio repleto: Estrenan serie documental “Agua Viva”
• Presidente Donald Trump anuncia aranceles a los socios comerciales de EE. UU.
• Claudio Figueroa de Mowi Chile: “La etapa de reproducción es clave en esta industria”
• Evolución sanitaria en la salmonicultura: De un modelo reactivo a una gestión preventiva y sostenible
objetivos. Agradezco al presidente del Directorio y a todos sus miembros por la confianza depositada y el apoyo entregado, señaló Vicente Swinburn.
Por su parte, Benjamín Holmes destacó: “Yadran ha sido mi casa durante más de 15 años, una etapa llena de aprendizajes y logros compartidos”.
SalmonChile intensifica gestiones por aranceles de EE. UU.
En respuesta a la reciente imposición de un arancel del 10% a las exportaciones chilenas por parte del gobierno de Estados Unidos, SalmonChile ha desplegado una intensa agenda de reuniones y gestiones para evaluar el impacto de esta medida y coordinar una estrategia conjunta con autoridades y otros sectores exportadores.
La medida, anunciada por el presidente Donald Trump el pasado 3 de abril y en vigencia desde el día 5 del mismo mes, se enmarca en una política de aranceles recíprocos hacia países con barreras comerciales con EE. UU. Para Chile, esto implica una afectación directa a una de sus principales exportaciones: El salmón. En 2024, las exportaciones de salmón y trucha de Chile alcanzaron un valor FOB de US$2.578 millones hacia el mercado estadounidense, lo que representa el 40% del total exportado por la industria. El 94% de estos envíos corresponde a sal-
món fresco transportado vía aérea, con un valor CIF que supera los US$4.125 millones.
Ante esta situación, el presidente de SalmonChile, Arturo Clément, señaló que el gremio ha mantenido reuniones clave para enfrentar esta contingencia. “Hemos seguido avanzando en las reuniones por el efecto de los aranceles que impuso el gobierno de Estados Unidos a los productos chilenos. En el día de ayer, nos reunimos en la mañana con AmCham (Cámara Chilena Norteamericana de Comercio), donde coordinamos acciones futuras entre ellos y los exportadores”, detalló Clément.

El dirigente gremial también participó en una sesión de la Comisión de Economía de la Cámara de Diputados, junto a autoridades como el canciller Alberto van Klaveren y representantes del Ministerio de Hacienda.
SalmonChile ha desplegado una intensa agenda de reuniones y gestiones para evaluar el impacto de esta medida.
ACTUALMENTE, LA REMEDIACIÓN DE SUELOS MARINOS SE
HA VUELTO CRUCIAL PARA LA INDUSTRIA ACUÍCOLA CON LA
IMPLEMENTACIÓN DE LA NORMATIVA DE 2024. EN RESPUESTA,
EMPRESAS ESTÁN INNOVANDO CON TECNOLOGÍAS Y SERVICIOS
ESPECIALIZADOS PARA APOYAR A LAS CONCESIONARIAS EN EL CUMPLIMIENTO DE LAS EXIGENCIAS MEDIOAMBIENTALES.
Con la entrada en vigencia en enero de 2024 de la nueva normativa sobre recuperación de fondos marinos, la industria acuícola en Chile debe adaptarse a nuevas exigencias que obligan a los concesionarios a presentar estudios de investigación y planes de recuperación acreditados por certificadores.
Desde enero de 2024, estas medidas han puesto en foco la importancia de la consultoría y las tecnologías de remediación para cumplir con la normativa y ayudar a recuperar los ecosistemas marinos.
En conversación con Revista AQUA, la doctora en Derecho de Acuiestudios y Magíster en Derecho Público de la Pontificia Universidad Católica de Valparaíso, Jessica Fuentes, analiza cómo afecta a las empresas acuícolas la nueva normativa sobre recuperación de fondos marinos, así como el rol que cumplen las consultoras especializadas en su implementación. Fuentes expresa que, a la fecha, como no se ha dictado la
normativa reglamentaria, por ahora están vigentes las disposiciones de la ley 21.410 que no requieren implementación reglamentaria. “Esta ley busca mayor efectividad en el objetivo de evitar y reducir la generación de desechos que se liberan al medio ambiente por parte de la actividad de acuicultura. Para ello distingue entre los desechos inorgánicos y los desechos orgánicos”, comenta.
La abogada explica que los desechos inorgánicos son aquellos que por su naturaleza pueden ser retirados. En general hablamos de objetos que pueden caer al medio, como parte de redes, flotadores, etc.
En este caso, se impone la obligación de adoptar medidas para evitar el depósito de estos desechos en el fondo de la concesión, transportarlos y disponerlos en medios y sitios autorizados. Estas disposiciones entraron en vigor a los seis meses de publicada la ley.
Agrega que respecto de los desechos orgánicos la situación es más compleja porque el retiro puro y simple puede causar dispersión y otras externalidades que deben ser evitadas porque son más perniciosas, tal como lo dejaron de manifiesto, durante la tramitación de la ley, distintos académicos y científicos de reconocida trayectoria. En este caso, se está hablando, por ejemplo, de las heces, alimento no consumido, en otros.
La doctora en Derecho de Acuiestudios asegura que, por este motivo, en el caso de los desechos orgánicos se plantea la necesidad que el titular de la concesión adopte

medidas para evitar o reducir el depósito de estos desechos en la concesión.
Además, especifica que se deben presentar planes de recuperación y de investigación del fondo marino, y precisamente los requisitos de tales planes deben ser regulados por el reglamento que se encuentra en elaboración.
Agrega que la propuesta reglamentaria incorpora algo que la ley 21.410 no menciona y que es la reducción de la producción en los casos en que un centro de cultivo obtenga una INFA (información ambiental) negativa, esto es, anaeróbica.
“Dicha medida se relaciona con un instrumento del reglamento ambiental para la acuicultura (RAMA), por lo cual estimo que se requiere un mayor análisis acerca de cómo tal medida es coherente con el resto del sistema planteado por el RAMA”, añade.
En ese sentido, Jessica Fuentes asegura que la propuesta reglamentaria conocida a la fecha es muy poco específica en cuanto a los requisitos y condiciones que deberán cumplir las empresas para dar cumplimiento a las exigencias de la ley.
“Y aún más, la nueva limitación que introduce relativa a la reducción de producción no está asociada a indicadores concretos que otorguen la predictibilidad necesaria para generar una planificación de acciones para evitar caer en el supuesto”, detalla.
La abogada explica que, de esta forma, es necesario esperar la nueva propuesta reglamentaria para conocer si la dicha versión constituye una regulación de mayor especificidad y profundidad.
“Tal como lo mandata la ley y que espera tanto el sector como la ciudadanía para otorgar la certeza necesaria de que los planes de recuperación y de investigación cumplirán el objetivo de aportar a la sustentabilidad de la actividad acuícola”, concluye.
Con la entrada en vigencia de la Ley 21.410 y su exigencia de planes de recuperación ambiental para las concesiones acuícolas, el sector enfrenta desafíos técnicos y regulatorios que requieren innovación y adaptación. Una de las empresas que ha desarrollado soluciones específicas para abordar estos requerimientos es DVS Tecnología.
Con el objetivo de conocer cómo se está abordando este nuevo escenario desde la industria, Revista AQUA conversa con el gerente general de la compañía, Daniel Vega, quien detalla que han creado dos servicios relacionados con el tratamiento de sedimentos, ya sea marino o de aguas continentales, dirigidos a abordar las consecuencias derivadas de la acumulación de materia orgánica, nutrientes y otros contaminantes de origen humano o natural.
“Estos servicios son el Servicio de Recuperación de Fondos (SRF) y el Servicio de Conservación de Fondos (SCF), dependiendo del grado de impacto ambiental del fondo al momento en que se realiza la aplicación”, asegura el ejecutivo.
Desde la compañía explican que el SRF se aplica sobre un sedimento que ya ha superado su Capacidad de Carga. Esto
“Esta ley busca mayor efectividad en el objetivo de evitar y reducir la generación de desechos”, Dra. Jessica Fuentes, abogada en Acuiestudios.
“Hemos creado dos servicios relacionados con el tratamiento de sedimentos, ya sea marino o de aguas continentales”, Daniel Vega, gerente general de DVS Tecnología.
sucede cuando un cuerpo de agua o un sedimento sobrepasa el punto de acumulación de biomasa más allá del cual cualquier aumento tendrá graves efectos sobre éste, o como se definió en el Taller de Sustentabilidad y Manejo a Largo Plazo de la Actividad Acuícola (Puerto Montt, enero 2010): “Es la habilidad natural del ecosistema para usar y descomponer contaminantes potenciales sin efectos perjudiciales para el ambiente”.
Por otro lado, añade que el SCF se aplica sobre un sedimento antes de que haya superado su Capacidad de Carga. “Se trata por lo tanto de una técnica de conservación preventiva, de manera de impedir que la biomasa alcance niveles que puedan tener efectos graves sobre ella, preservando así intacta la capacidad natural del ecosistema para usar y descomponer contaminantes potenciales”, asegura.
La empresa afirma que ambas técnicas, SRF y SCF se aplican sobre la base de un equipo hidromecánico denominado
Desplazador de Masas de Agua (DMA) que ha sido desarrollado y patentado por DVS, el cual puede trabajar en distintas configuraciones, tanto para hacer surgencia, y desplazar agua profunda hacia la superficie, como en convergencia, “que dependiendo de la profundidad en que se ubique la Tobera del DMA, podrá desplazar agua superficial o subsuperficial hacia el fondo sedimentario, en un rango mínimo de 3,5 metros hasta un máximo de 140 metros de profundidad”, expresa.
“Esta agua se caracteriza por su enriquecimiento natural con oxígeno disuelto y su abundancia en microorganismos planctónicos. El proceso implica dirigir un flujo de 1.200 litros por segundo hacia el fondo sedimentario”, explica.
En cuanto a los principales factores que dificultan una remediación efectiva y oportuna en los fondos marinos concesionados, la intervención dependerá del “grado de Impacto que tenga el sedimento (cobertura de Bacterias y/o alteración de parámetros físicos-químicos y biológicos). Y el factor Climático (condiciones climáticas que puedan impedir una normal operación)”, asegura Daniel Vega.
“Y finalmente las contingencias por Motivos de Fuerza Mayor, tales como Tsunami, terremotos, pandemias o similares, que impidan la normal aplicación de la técnica de recuperación”, especifica.
Para los dos primeros aspectos, la compañía está en condiciones de evaluar y determinar con el resultado del Mapeo y realizar una predicción del plazo que necesitará para desarrollar su operación. Esta predicción se basa en la experiencia acumulada por DVS a través del tiempo.
“El factor climático guarda una estrecha relación con la ubicación geográfica de la Concesión o del sitio que se va a intervenir, y su impacto en la duración total de la faena puede ser significativo”, comenta.
DVS Tecnología en faena con personal operando sobre plataforma.
Desde DVS Tecnología, enfatizan que la aplicación de las técnicas SRF y SCF mediante el empleo del equipo DMA en modo de operación en convergencia constituye un método eficaz para la utilización de agua marina, ya sea superficial o subsuperficial.

En este sentido, dado que el mandante es quien mejor conoce el sector donde realiza sus operaciones, se encuentra en la posición óptima para evaluar y anticipar el impacto que las condiciones climáticas podrían tener en la operación.
“También puede identificar las épocas del año más propicias para llevar a cabo una operación normal de Servicio de Recuperación de Fondos (SRF) o Servicio de Conservación de Fondos (SCF)”, concluye.
Por su parte, Poseidon es una de las empresas que ha desarrollado soluciones innovadoras para apoyar la remediación de fondos marinos. La compañía ha creado tecnologías para optimizar la oxigenación y facilitar intervenciones que aseguren la estabilidad del ecosistema.
Aunque no realiza directamente labores de remediación o estudios ambientales, sus sistemas entregan soporte técnico para la ejecución de estas acciones por parte de los productores.
En conversación con Revista AQUA, el gerente Comercial de Poseidon, Mauricio Cerda, explica cómo estas herramientas pueden ser integradas en los procesos de evaluación y recuperación de suelos marinos, especialmente en escenarios geográficos o climáticos complejos.
El ejecutivo es enfático en mencionar que Poseidon Ocean Systems no realiza directamente trabajos de remediación, pero pone a disposición de productores y empresas especializadas una suite modular de Life Support Systems diseñados para optimizar el bienestar animal y mejorar las condiciones del entorno marino.

“Estas tecnologías proporcionan la capacidad de generar y difundir aire y oxígeno, lo que es el corazón para que cualquier faena de este tipo pueda realizarse de manera óptima”, agrega.
Cerda detalla que entre estas soluciones destaca el Oxypressor, un sistema de generación de oxígeno de alta eficiencia. Su diseño versátil permite integrarse fácilmente con casi cualquier sistema de oxigenación existente, incluidas mangueras porosas, sistemas de nanoburbujas o la tecnología de difusión Depth Charge de Poseidon.
Añade que está diseñado para operar en condiciones extremas y ubicaciones remotas, lo que lo hace ideal para concesiones en zonas de difícil acceso.
El gerente Comercial afirma que, si bien Poseidon no realiza estudios ambientales ni planes de recuperación directamente, sus soluciones tecnológicas aportan datos críticos para la gestión sustentable del entorno acuícola.
“El sistema Sentinel permite monitorear en tiempo real variables como presión, flujo de aire, consumo de combustible, temperatura y niveles de oxígeno, entregando información precisa y oportuna para la toma de decisiones”, expresa.
Desde la compañía agregan que esto facilita a los operadores cumplir con los requisitos técnicos y ambientales exigidos por los certificadores, al contar con evidencia continua del estado del sistema y su impacto positivo en el entorno.
Por otro lado, enfatizan que actualmente uno de los principales obstáculos puede ser la falta de sincronía entre la operación productiva y la implementación de medidas correctivas, sumado a la complejidad de operar en condiciones geográficas y climáticas desafiantes.
En este contexto, el ejecutivo comenta que las tecnologías
como el Oxypressor, con su capacidad de adaptación a distintos sistemas y ambientes extremos, se convierten en una herramienta estratégica. Además, la versatilidad que le permite trabajar con diferentes sistemas de difusión también es una ventaja para lograr remediaciones efectivas.
“Su uso permite mantener una oxigenación estable y eficiente incluso en sitios alejados, asegurando el bienestar de los peces y colaborando indirectamente en mantener las condiciones adecuadas del fondo y entorno marino”, concluye.

“Uno de los principales obstáculos puede ser la falta de sincronía entre la operación productiva y la implementación de medidas correctivas”, Mauricio Cerda, gerente Comercial de Poseidon.
LA ADOPCIÓN DE TECNOLOGÍAS COMO ULTRASONIDO, PLASMA
FRÍO Y LUZ UV-C OPTIMIZAN LA DESINFECCIÓN, CUMPLEN CON
NORMATIVAS COMO RSA Y CODEX ALIMENTARIUS, Y FORTALECEN
LA COMPETITIVIDAD DEL SECTOR GRACIAS A LA COLABORACIÓN
ENTRE INDUSTRIA, ACADEMIA Y AUTORIDADES.
En los últimos años, se ha observado una evolución significativa en las estrategias de bioseguridad y desinfección dentro de las plantas de proceso acuícola, motivada tanto por exigencias del mercado como por la preocupación de prevenir brotes de patógenos que pueden afectar la continuidad operacional.
En este sentido, “la incorporación de tecnologías emergentes como el ultrasonido, micro y nano burbujas, plasma frío atmosférico (PFA), iones hidroxilos, luz ultravioleta (UV-C) y especies reactivas como ozono, entre otros, han permitido diversificar los métodos de sanitización más allá de los químicos tradicionales, ofreciendo soluciones más sostenibles y menos agresivas para los materiales y el medio ambiente”, comenta el académico del Instituto de Ciencia y Tecnología de los Alimentos (Icytal) de la Facultad de Ciencias Agrarias y Alimentarias de la Universidad Austral de Chile, Aníbal Andrés Concha Meyer.
Añade que “estas tecnologías permiten actuar sobre superficies, ambientes y agua de proceso, con una alta eficiencia
microbiana, reduciendo la carga de patógenos de preocupación tales como Listeria monocytogenes, Salmonella spp. y Vibrio spp., sin dejar residuos tóxicos. La validación científica y la transferencia tecnológica han sido claves para su adopción progresiva, especialmente en líneas de productos frescos y congelados donde la inocuidad y la calidad sensorial son críticas”, afirma.
Estas medidas tecnológicas se alinean estrechamente con normativas internacionales como el Codex Alimentarius, los lineamientos de la FDA (EE. UU.) y la EFSA (UE), todas las cuales enfatizan un enfoque basado en riesgos y la aplicación de sistemas preventivos como HACCP para garantizar la inocuidad.
“En el contexto nacional, el Reglamento Sanitario de los Alimentos (RSA) de Chile también ha evolucionado para permitir enfoques tecnológicos innovadores. Un ejemplo concreto es el artículo 174, que establece que, excepcionalmente, para alimentos que favorecen el desarrollo de Listeria monocytogenes, se puede aplicar el criterio más flexible (≤ 100 ufc g-1 durante la vida útil), siempre que el fabricante o productor pueda garantizar y demostrar que el producto no superará ese límite mediante tecnologías validadas”, detalla el académico de la UACh.
“Desde mi experiencia, esto refuerza la importancia de establecer colaboraciones entre industria, academia y autoridades sanitarias para asegurar el cumplimiento regulatorio y, al mismo tiempo, mejorar la competitividad de los productos frescos y congelados en mercados exigentes”, agrega Aníbal Concha.

E INTERNACIONALES
A nivel nacional, en Chile, los estándares están definidos por reglamentos del Servicio Nacional de Pesca y Acuicultura (Sernapesca) y del Ministerio de Salud (Reglamento Sanitario de los Alimentos), los cuales recogen principios de bioseguridad y buenas prácticas de manufactura (BPM). Internacionalmente, normas como ISO 22.000, BRCGS, IFS Food y el sistema HACCP son referentes claves.
El académico del Instituto de Ciencia y Tecnología de los Alimentos de la UACh recuerda que, “en el caso de productos acuícolas, los principales patógenos a controlar incluyen Listeria monocytogenes, Salmonella spp., Shigella spp, E. coli patogénicas (STEC y ETEC), Vibrio parahaemolyticus, y Clostridium botulinum, además de virus como el Norovirus y el Hepatitis A en productos bivalvos. La implementación de nuevas tecnologías debe considerar su capacidad real de inactivación de estos microorganismos, bajo condiciones validadas y dentro de un marco de aseguramiento de calidad robusto”.
El académico sostiene que la industria acuícola, pesquera y agroalimentaria enfrentan exigencias crecientes en sostenibilidad, trazabilidad, inocuidad y calidad, lo que ha redefinido el perfil profesional requerido a nivel transversal dentro de las empresas.
“Por ello, desde la Universidad Austral de Chile estamos trabajando en actualizar los programas formativos de programas de pregrado y postgrado, para conectar la investigación
aplicada con la transferencia tecnológica y la innovación al servicio de la producción segura y eficiente de alimentos”, comenta Aníbal Concha Meyer.
Sobre las actuales soluciones para estos requerimientos, la Brand Manager de Citrex Chile, Loreto Sanhueza, destaca que, “en los últimos años, la industria acuícola ha experimentado avances significativos en bioseguridad y desinfección, impulsados por la necesidad de garantizar la inocuidad de los alimentos y cumplir con normativas cada vez más exigentes. La implementación de tecnologías como sistemas automatizados de limpieza, productos biodegradables y protocolos de desinfección adaptados a ambientes de baja temperatura ha optimizado los procesos y reducido riesgos sanitarios”.
“En este contexto, TREX D® NO FROST de Citrex Chile se ha consolidado como una solución innovadora para la limpieza en ambientes de refrigeración y congelación extrema. Su fórmula avanzada permite una limpieza profunda sin necesidad de descongelar las cámaras previamente, asegurando eficiencia y seguridad en plantas procesadoras acuícolas”, comenta Loreto Sanhueza.
Enfatiza que las medidas de bioseguridad y desinfección deben cumplir con estándares internacionales como el Codex Alimentarius, que establece criterios de calidad e inocuidad para productos congelados y frescos. “Además, la aplicación de sistemas de Análisis de Peligros y Puntos Críticos de Control
Despinado de salmón en planta de proceso.
“Estas tecnologías permiten actuar sobre superficies, ambientes y agua de proceso, con una alta eficiencia microbiana”, académico de la UACh, Aníbal Andrés Concha Meyer.
Producto y tecnología de para bioseguridad y desinfección.

(HACCP) es fundamental para garantizar la seguridad alimentaria en toda la cadena de producción”, afirma.
La ejecutiva recuerda que TREX D® NO FROST y otros productos de Citrex Chile están diseñados para cumplir con estos estándares, ofreciendo soluciones biodegradables y no tóxicas que minimizan riesgos para el operador y el medio ambiente.
son el agua y la sal. “Esto combinado con nuevos sistemas de monitoreo y control avanzado permiten una desinfección efectiva, con una eficacia óptima y evitando la sobredosificación. Antes el uso de HOCl resultaba prohibitivo, pero el avance tecnológico ha permitido una reducción importante de costos que ha ampliado enormemente el abanico de aplicaciones”, recuerda Pizarro.
Añade que “de especial interés para las plantas de proceso acuícola es la excelente efectividad que ha mostrado HypoShield para combatir la listeria y salmonella en los puntos críticos. Respecto de la calidad y la inocuidad de productos frescos, existen estudios que han comprobado que una nebulización con ácido hipocloroso puede ampliar en varios días la vida útil del producto, al bajar considerablemente los niveles de bacterias y virus”.
“Para productos congelados, es posible generar hielo estéril con HOCl, lo que también aumenta considerablemente la vida útil del producto y reduce los riesgos de contaminación cruzada, asegurando que en el país de recepción el producto venga libre de problemas”, agrega.
HypoShield ofrece ácido hipocloroso envasado en bidones e IBC para su uso en cualquier aplicación listada en el punto 3, especialmente pensando en la inocuidad para los mercados externos.
“La industria acuícola ha experimentado avances significativos en bioseguridad y desinfección”, Brand Manager de Citrex Chile, Loreto Sanhueza.
“El uso de productos especializados como TREX D® NO FROST contribuye a mejorar la eficiencia operativa y reducir riesgos sanitarios, asegurando el cumplimiento de estos estándares y optimizando los procesos de limpieza en condiciones extremas”, describe.
Para garantizar el cumplimiento de normativas sanitarias en mercados internos y externos, Citrex Chile ofrece una línea de productos diseñados para la limpieza y desinfección en la industria acuícola. “Además de TREX D® NO FROST, destacan soluciones para el control de patógenos, neutralización de olores y desinfección de superficies, todas formuladas con ingredientes biodegradables y seguros”, complementa Loreto Sanhueza.
En tanto, el director general de HypoShield, Alejandro Pizarro, detalla que, “nuestra propuesta de valor para la acuicultura es la desinfección con ácido hipocloroso, también conocido como Anolyte o Agua electrolizada (HOCl). Es un desinfectante que tiene muchas cualidades deseables como inocuidad para el ser humano y animales, es biodegradable, orgánico (certificado por el SAG), no corrosivo, de pH neutro y extremadamente efectivo contra virus, bacterias, hongos, e incluso biofilm”. Destaca que el principal avance tecnológico que ha ocurrido en los últimos años es que ahora existe la capacidad de generar el ácido hipocloroso en grandes cantidades; incluso en el punto de uso a partir de insumos extremadamente simples, como lo
“Para clientes que necesiten grandes volúmenes, es posible instalar una máquina de producción in situ, que por su gran capacidad es capaz de cubrir todas las necesidades de desinfección de no solo una planta de proceso, sino que también de sitios de cultivo. Además, considerando la normativa interna y la seguridad de los trabajadores, HypoShield es completamente inocuo y no existe la posibilidad de accidentes laborales, como sí pueden ocurrir usando desinfectantes peligrosos como el amonio cuaternario o el ácido peracético”, comenta Alejandro Pizarro.
El gerente técnico SGS Chile, Pablo Santibáñez, remarca que, “en la actualidad, las plantas de proceso focalizan sus esfuerzos en la aplicación correcta de los distintos agentes desinfectantes en los ambientes de proceso, considerando quiebres microbiológicos, aseo entre turnos y aseo de remate como puntos de alto interés”.
“Esta actividad, aparentemente sencilla, en realidad requiere un alto grado de entrenamiento para los colaboradores a cargo de la actividad, desde conceptos básicos como preparación de disoluciones y manejo de fichas de seguridad, a la internalización de los riesgos microbiológicos y sus impactos en la salud de las personas. Es importante indicar que la mayoría de las plantas tienen un programa de rotación de químicos en los cuales van alternando con cierta frecuencia definida su uso, lo cual permite reducir los riesgos de generación de resistencia a los procesos de desinfección”, afirma Santibáñez.
Añade que en el horizonte, actualmente se está explorando o aplicando según el caso, el uso de luz UV y ozono en la desinfección de aguas o en superficies (según el tipo de industria), las cuales pueden tener una aplicación real en distintas etapas
productivas de las líneas. Más lejano está el uso de agentes de biocontrol, como probióticos o proteínas inhibidoras de crecimiento microbiano. Debido a regulación y lo complejo de su validación, aún materia de investigación y discusión el uso de este tipo de compuestos en los alimentos o ambientes.
“Adicionalmente, no podemos dejar de lado el monitoreo y automatización de procesos, en el sentido de que en un futuro cercano los procesos de ejecución de estas actividades de higiene podrían tener cierto grado de automatización o planificación usando la IA, tales como la indicación del momento en que se debe realizar el quiebre microbiológico o supervisar como fue realizada la actividad de higiene, entre otros”, comenta Pablo Santibáñez.
“Hoy cada planta de proceso dentro de su programa operacional de saneamiento debe definir los protocolos y mecanismos de control de sus procesos. Esto es un prerequisito para poder optar a la autorización para funcionar bajo un programa HACCP”, sostiene el gerente técnico de SGS Chile.
Luego de implementado un HACCP, una de las normativas que tiene más fuerza en la industria acuícola nacional es BAP (Best Aquaculture Practices), la que incluye aspectos relacionados con la higiene y la inocuidad alimentaria. Los estándares BAP aseguran que los productos acuícolas se produzcan bajo condiciones higiénicas que minimicen riesgos de contaminación y garanticen la seguridad alimentaria, teniendo requisitos asociados a limpieza y desinfección , control de plagas , salud ocupacional y evaluaciones de riesgo relacionadas con la higiene y la seguridad
“La evolución se ha visto en gran medida a nivel del entrenamiento del personal que realiza la operación, debido a que son un eslabón inicial y crítico en asegurar las condiciones sanitarias de la panta de procesos, donde el concepto de cultura de inocuidad como es definido por GFSI (Global Food Safety Initiative), encaja perfectamente”, recuerda Pablo Santibáñez.

“Hoy específicamente en el área de desinfección, en los soportes integrales que la industria puede evaluar es hacer estudios de eficacia de desinfectantes con el agente químico que utilizan rutinariamente en los procesos rutinarios de higiene”, detalla.
“Recientemente hemos lanzado un modelo de evaluación de riesgo integral, el cual considera variables involucradas en la calidad final del producto, como la higiene, genotipos presentes, ambiente productivo, persistencia y prevalencia, entre otros. Todas las variables en su conjunto ofrecen una perspectiva del estado sanitario de la planta, lo cual es una herramienta útil al momento de hacer gestión y planificación estratégica del departamento de calidad”, concluye el gerente técnico de SGS Chile.
“Hemos lanzado un modelo de evaluación de riesgo integral, el cual considera variables involucradas en la calidad final del producto”, gerente técnico de SGS Chile, Pablo Santibáñez.
CON LA LEY REP EN EL HORIZONTE Y LA LUPA DE LOS MERCADOS
INTERNACIONALES SOBRE SU DESEMPEÑO AMBIENTAL, LA
ACUICULTURA CHILENA AVANZA DESDE LA MERA GESTIÓN DE RESIDUOS HACIA CADENAS CIRCULARES.
La salmonicultura y la mitilicultura chilenas han conquistado mercados globales con un relato de eficiencia productiva y generación de empleo en las regiones del sur. Hasta hace poco, sin embargo, ese éxito económico convivía con una larga lista de materiales expulsados del ciclo productivo: Boyas de poliestireno expandido (EPS) que aparecían varadas en las costas, conchas de chorito amontonadas junto a las plantas de proceso y toneladas de plásticos, cartones y residuos mixtos que concluían su vida útil en rellenos sanitarios o vertederos clandestinos.
Hoy el escenario empieza a cambiar de la mano de gestores que, por convicción y negocio, se han propuesto demostrar que cada desecho contiene un valor.
Entre 2015 y 2024 la producción nacional de salmón creció cerca de 30%, y la mitilicultura duplicó la capacidad de sus plantas de proceso. Esa expansión colisionó con una normativa medioambiental cada vez más exigente y con consumidores que asocian la sostenibilidad a criterios verificables. Las empresas exportadoras entendieron que el problema de los residuos ya no podía resolverse con fletes a cientos de kilómetros ni con declaraciones voluntarias. Al mismo tiempo, la Ley de
Responsabilidad Extendida del Productor (Ley REP) y su nuevo sistema de reporte digital -SISREP- obliga desde enero de 2025 a declarar mensualmente cada kilo de envases y embalajes puesto en el mercado y a exhibir metas de valorización. Frente a ese doble impulso —mercado y regulación— las alianzas con gestores especializados dejaron de ser una opción periférica y pasaron al tablero principal de la estrategia.
En Puerto Aysén, el CEO de Aysén Circular, Fernando SotoAguilar, dirige una planta donde llegan flotadores y boyas de EPS, recolectados en centros de cultivo de AquaChile, Mowi, Cermaq y Cooke. Tras un proceso de compactación, molienda y extrusión, el material se transforma en paneles SIP que terminan convertidos en viviendas de alta eficiencia energética.
“En Aysén Recircular trabajamos bajo un modelo de negocio innovador que conecta dos industrias clave de la región: La salmonicultura y la construcción, utilizando la economía circular como eje central. Transformamos residuos de poliestireno expandido (EPS), como boyas y flotadores de la industria acuícola, en productos de alto valor agregado para la construcción sostenible, como paneles SIP (Structural Insulated Panels) y resinas recicladas”, explica el ejecutivo. Hasta la fecha la empresa ha reciclado más de 3.000 boyas y ha participado en 75 proyectos habitacionales, resultados que ilustran la premisa de su fundador: Ningún residuo entra

a la cinta sin la certeza de una demanda aguas abajo. No se trata de almacenar materia prima a la espera de un comprador hipotético, sino de integrar la lógica constructiva —subsidios habitacionales del Ministerio de Vivienda incluidos— con la curva de generación de residuos. En la práctica, cada flotador reciclado evita 200 litros de vertedero y sustituye materiales tradicionales de alto impacto, lo que reduce la huella de carbono y los costos de calefacción hasta en 50% para las familias patagónicas.
La experiencia, insiste Soto-Aguilar, comprueba que la economía circular solo despega cuando existe un sector capaz de absorber la materia valorizada. Y la construcción, cuyo déficit nacional supera las 600.000 viviendas, ofrece volumen y urgencia suficientes para sostener la ecuación.
Setecientos kilómetros al norte, las sucursales de Resiter en Puerto Montt, Castro y Chonchi reciben los restos de empaques, plásticos, cartón y orgánicos de los grandes procesadores de salmón. Su gerente general, Alejandro Valencia, explica que el salto conceptual radica en diagnosticar, no solo en transportar:
“En la industria salmonicultora, el principal servicio es la gestión integral de residuos con el objetivo de lograr consolidar operaciones ‘Cero Residuo a Relleno Sanitario’. Para esto, implementamos todos los servicios logísticos necesarios, pero en paralelo realizamos actividades de diagnóstico y análisis de
los residuos generados, para lograr un tratamiento eficiente por cada corriente residual. Un buen diagnóstico nos permite realizar propuestas de trabajo muy eficientes para que el sistema productivo de las salmonicultoras logre reducir al mínimo posible los residuos no valorizables”, explica Valencia.
El principio rector se despliega en dos líneas. La primera, logística: Compactadores automáticos, sensores y rutas de recolección que minimizan fletes vacíos. La segunda, industrial: Plantas de acondicionamiento que aumentan la densidad del residuo antes de enviarlo a su valorización final. Un ejemplo es Calagro, filial de Resiter que transforma 320.000 toneladas anuales de conchas de chorito en cal agrícola pulverizada; el subproducto contiene una huella de carbono menor que la cal minera y satisface una demanda creciente entre agricultores que buscan corregir pH sin costosos insumos químicos.
El mismo abordaje se aplica a plásticos y cartones, que se convierten en pellets, polvos o fardos para industrias papeleras. Para certificar el recorrido, Resiter mantiene una plataforma de trazabilidad conectada al RETC y colabora con AENOR en auditorías de “Residuo Cero”, ofreciendo a sus clientes un sello que se alinea con los requerimientos de las cadenas de retail europeas.
En Coyhaique, Rommy Osorio encabeza Paz Recycling, un emprendimiento de triple impacto que combina servicios de
La Ley REP obliga a declarar mensualmente cada kilo de envases y embalajes puesto en el mercado.
“Transformamos residuos de poliestireno expandido (EPS), como boyas y flotadores de la industria acuícola, en productos de alto valor agregado para la construcción sostenible”, explica el CEO de Aysén Circular, Fernando SotoAguilar.
Aysén Circular busca conectar la acuicultura con la construcción.
“Un buen diagnóstico nos permite realizar propuestas de trabajo muy eficientes para que el sistema productivo de las salmonicultoras”, menciona el gerente general de Resiter, Alejandro Valencia.

gestión con educación ambiental e inclusión de recicladores de base. La fundadora describe su propuesta en un tono que mezcla vocación social con rigor técnico.
En entrevista con Revista AQUA, la ejecutiva explica que “Paz Recycling Spa ofrece un servicio con enfoque de triple impacto (económico, ambiental y social) a todos sus clientes de la industria acuícola, brindando soluciones personalizadas y específicas según las necesidades de cada empresa. Nuestros servicios comienzan con la educación ambiental, centrada en la economía circular y la filosofía de cero residuos. Proporcionamos asesoría técnica en terreno e implementamos puntos de reciclaje, además de ofrecer la recolección de residuos, pretratamiento, destrucción de productos, reciclaje y valorización de residuos sólidos no peligrosos”.
La empresa ha gestionado 1.500 toneladas de material -plásticos, celulosas, metales y textiles- y destina parte de la materia prima recuperada a la fabricación de merchandising corporativo: Llaveros, posavasos y chips de madera provenientes de pallets industriales. El diferencial se resume en tres pilares: Infraestructura móvil que llega a pisciculturas y centros de mar, trazabilidad certificada en la Ventanilla Única RETC y participación de recolectores locales, quienes reciben capacitación y un pago justo por su trabajo.
Osorio subraya que el foco en residuos “difíciles” -mezclas de plástico con restos orgánicos o alta humedad- le otorga una ventaja competitiva, ofreciendo pretratamiento, compactación y destrucción de marca, garantizando confidencialidad al cliente y cierre de ciclo al residuo.
Las tres empresas reconocen que la Ley REP actúa como
metrónomo. La obligación de informar al SISREP cada kilo de envases y embalajes, sumada a la presión de los compradores internacionales, impone objetivos medibles. Resiter utiliza su plataforma para transferir a las autoridades el registro de cada tonelada manejada y Paz Recycling, por su parte, integra la Ventanilla Única y despliega certificados que describen CO₂ evitado y destino final de los residuos.
Aunque las metas iniciales se concentran en envases, la industria acuícola ya discute extender la trazabilidad a redes, cabos y restos de mortalidad, áreas donde aún existen vacíos tecnológicos. Las inversiones previstas incluyen líneas de lavado en frío -para no dañar fibras plásticas- y hornos de secado que permitan vender materia prima con especificaciones internacionales.
Y MERCADO INTERNO
El denominador común de las tres experiencias es la búsqueda de un “eslabón ancla” capaz de absorber material constante. En Aysén Recircular esa ancla es la construcción social; en Resiter, la agricultura que demanda carbonato de calcio; en Paz Recycling, el mercado corporativo que requiere merchandising con trazabilidad.
Valencia enumera los proyectos de expansión y se apresura a recalcar que la frontera ya no es técnica, sino de coordinación: “Tenemos varios proyectos muy interesantes para llegar a nuevas zonas geográficas, o bien, para tratar algunos residuos particulares que aún son un desafío. La idea es que las industrias sean cada vez más limpias y nosotros como Resiter tenemos un desafío gigante, que es armar modelos de economía circular, invirtiendo en tecnología e
innovación, para minimizar el impacto ambiental de nuestros clientes y propio”.
Osorio coincide y adelanta que su hoja de ruta incluye máquinas de clasificación óptica y acuerdos con plantas del norte para procesar residuos sin mercado local: “En los próximos dos a tres años, Paz Recycling planea implementar innovaciones en sus procesos de reciclaje mediante la incorporación de nuevas máquinas y tecnologías avanzadas que optimicen la eficiencia en la producción y la efectividad en la gestión de residuos, brindando soluciones para residuos que aún no tienen posibilidades de valorización”.
Soto-Aguilar, en tanto, ve una oportunidad directa en la política habitacional: “Uno de nuestros principales objetivos es posicionar nuestros paneles SIP en el mercado de los subsidios habitacionales, ya que contamos con la certificación del Minvu, lo que valida la calidad y el desempeño de nuestros productos. Este paso aumentaría la escala de nuestros proyectos, permitiendo llevar soluciones constructivas sostenibles y eficientes a un mayor número de comunidades locales”.
La acuicultura chilena enfrenta una década de escrutinio público por su impacto ambiental y una carrera contra el tiempo para cumplir nuevas exigencias regulatorias. La buena noticia es que las respuestas están emergiendo dentro del propio ecosistema productivo. Aysén Recircular convierte los residuos voluminosos en abrigo térmico; Resiter canaliza conchas y plásticos hacia insumos agrícolas y papeleros; Paz Recycling añade valor social al incorporar recolectores de base y educación ambiental. Juntas, estas iniciativas ilustran un cambio cultural que desplaza la palabra “basura” y la reemplaza por “recurso en tránsito”.

La economía circular dejó de ser un relato aspiracional para transformarse en un mandato operativo, amarrado a balances de carbono, licencias sociales y márgenes financieros. En los próximos años la discusión ya no será si es posible reciclar o remanufacturar -la tecnología y los modelos están probados- sino quién lo hace de forma más eficiente, trazable y beneficiosa para su comunidad. En ese punto la competencia dejará de medirse solo en toneladas de salmón exportado y sumará un nuevo indicador: Cuántos kilos de residuo se logran rescatar antes de que vayan a disposición final.

“Nuestros servicios comienzan con la educación ambiental, centrada en la economía circular y la filosofía de cero residuos”, asegura Rommy Osorio, fundadora de Paz Recycling.
Acuerdos de Producción Limpia
LOS APL ESTÁN IMPULSANDO UN CAMBIO HACIA LA SOSTENIBILIDAD
EN LA ACUICULTURA CHILENA, PROMOVIENDO LA ECONOMÍA
CIRCULAR, LA EFICIENCIA ENERGÉTICA Y UNA GESTIÓN DE RESIDUOS MÁS RESPONSABLE EN SECTORES COMO LA SALMONICULTURA Y LA MITILICULTURA.
Los Acuerdos de Producción Limpia (APL) se han consolidado como una herramienta relevante para impulsar la sostenibilidad en la acuicultura chilena, especialmente en los distintos sectores productivos vinculados a esta actividad.
Se trata de convenios voluntarios de carácter públicoprivado que han permitido a empresas avanzar en la gestión ambiental, la eficiencia energética, la valorización de residuos y el desarrollo de economías circulares.
En este contexto, Revista AQUA conversa con la Agencia de Sustentabilidad y Cambio Climático (ASCC) de Corfo, entidad que ha impulsado Acuerdos de Producción Limpia (APL) tanto en el sector salmonicultor como mitilicultor.
“Con el sector productor de salmones, se está trabajando un APL que está liderando SalmónChile, con la ejecución del Intesal”, mencionan.
Desde la institución explican que, en este APL, el sector —compuesto por las empresas productoras de salmón y su cadena de valor (fabricantes de alimentos y proveedores de
servicios e insumos)— con operaciones en la regiones del Biobío, Los Lagos y Aysén, se ha comprometido a elaborar una estrategia de cambio climático y economía circular para la industria salmicultora.
Por otra parte, desde la ASCC afirman que se está desarrollando la segunda versión del APL con el sector de mitílidos, tras una primera etapa que logró la certificación de 31 empresas con 44 instalaciones de la industria del mejillón en la región de Los Lagos.
Este segundo APL busca profundizar los cambios en la industria y, entre otros beneficios, permite el acceso a tasas preferenciales en créditos, facilitando así la inversión en tecnología y prácticas sostenibles.
En este, las empresas se comprometen a implementar alternativas y soluciones para el reciclaje y la valorización de residuos sólidos. Además, se establecerán unidades territoriales para la limpieza de playas y la gestión de residuos.
La Agencia detalla que los APL han sido fundamentales para avanzar en la sustentabilidad del sector acuícola nacional, ya que permiten articular a las empresas chilenas con los servicios públicos con competencia en las materias ambientales y con las comunidades.
De esta forma, comentan que se generan economías de escala que facilitan un avance más rápido y coordinado hacia el cumplimiento de las metas ambientales del sector.
Por ejemplo, las empresas al trabajar de modo conjunto pueden generar estrategias de colaboración horizontal para

resolver problemas como las emisiones de gases de efecto invernadero o la gestión de residuos sólidos, además de coordinar sus inversiones sociales.
“De esta forma, la colaboración público-privada se posiciona como un elemento clave para avanzar en los grandes desafíos ambientales del país”, expresan.
Por ejemplo, “entre los principales logros alcanzados en el primer APL con la industria mitilicultora, los centros de cultivo MYPYME lograron un aumento del 10% en la valorización de residuos sólidos, mientras que en los centros de cultivos grandes el incremento fue del 11,2%”, mencionan.
“Las conchillas fueron el residuo más valorizado, alcanzando un 99%, lo que equivale a 8.977 toneladas. Para lograr estos resultados, se realizó una inversión promedio de $8,5 millones por centro de cultivo MYPIME”, detallan.
En ese sentido, especifican que, en cuanto a las plantas de proceso, el 100% de las instalaciones realizaron inversiones para mejorar las tasas de consumo de electricidad y realizaron capacitaciones en eficiencia energética.
“Esto generó una disminución del 3% en el consumo de electricidad por tonelada de materia prima producida. La inversión promedio en medidas de gestión energética fue superior a los $48 millones”, asegura la institución.
“Por su parte, durante el segundo semestre de este año se espera contar con los resultados del APL con la industria del Salmón, los cuales se proyectan igual de exitosos como los alcanzados en el sector mitilicultor”, concluyen.
En este contexto, Revista AQUA conversa con Sonia Medrano, gestora tecnológica del Instituto Tecnológico de la Miticultura (Intermit), que pertenece a la Asociación de Mitilicultores de Chile (AmiChile), quien entrega detalles sobre la implementación del segundo APL en el sector. “Ya estamos en el segundo Acuerdo de Producción Limpia, en el cual se han integrado 18 empresas y 31 instalaciones”, explica.
Sonia Medrano afirma que actualmente varias de estas empresas ya formaron parte del primer acuerdo y hoy continúan en este proceso con algunas de sus instalaciones. Así, para muchas de ellas —especialmente las más grandes— se ha tratado de un proceso continuo en el tiempo.
“El gran desafío, sin duda, es mejorar en general los indicadores de sustentabilidad dentro de la industria”, agrega.
Medrano detalla que entre estos desafíos se encuentran mejorar la eficiencia energética, la huella hídrica, fortalecer el vínculo y el relacionamiento con las comunidades, optimizar la gestión de residuos e incursionar en temas relacionados con la sostenibilidad de la semilla, un insumo crítico para la industria mitilicultora.
“En definitiva, se trata de avanzar continuamente en la mejora y construcción de prácticas más sostenibles. Ya en el primer acuerdo se trabajaron algunos indicadores de sostenibilidad, y hoy se están incorporando nuevos indicadores”, añade.
Esto no solo beneficia a la industria, sino que también
Empresa Landes en Chiloé.
“Ya estamos en el segundo Acuerdo de Producción Limpia, en el cual se han integrado 18 empresas y 31 instalaciones”, Sonia Medrano, gestora tecnológica del Instituto Tecnológico de la Miticultura.

permite que la comunidad conozca los avances y el compromiso continuo de la industria y los cultivadores con la mejora ambiental de la mitilicultura.
Como ejemplo, dentro de este acuerdo existe una meta muy importante relacionada con la gestión de residuos y otras acciones que son clave. “Buscamos como mejorar y desarrollar una economía circular en torno a las conchillas, promoviendo su valorización”.
planta de proceso, indicaba también cómo sus centros de cultivo necesitaban avanzar en materia de gestión ambiental y sostenibilidad.
“Este primer acercamiento con los APL del sector mitilicultura nos permitió trazar un camino en busca de una mejora continua en la gestión ambiental de nuestros centros, que más tarde nos llevaría a certificar nuestros centros en normas internacionales, como ASC”, especifica.
El ejecutivo explica que los indicadores ambientales, controles para la cuantificación de los residuos y su segregación, la cuantificación de huella de carbono desde 2020, la que con el segundo APL tendrá una línea base de la industria con la cual medirse para mejorar prácticas que permitan una reducción en la generación de CO2.
“El APL de mitilicultura actual nos ayuda a conocer el estado de la industria, así como generar lazos y visibilizar al sector para mejorar como gremio”, detalla.
Entre las acciones que impulsa este nuevo APL, se encuentran las unidades territoriales, las que, al conformarse, les ayudarán a mantener un orden sobre la limpieza del borde costero en un trabajo más colaborativo, entre todos los centros de área y las comunidades circundantes.
“El APL de mitilicultura actual nos ayuda a conocer el estado de la industria”, Aldo Soldano, gerente de Operaciones Landes Mussels.
“La industria genera un gran volumen de residuos de conchillas, y actualmente contamos con una capacidad importante en la zona para valorizarlos, a través de plantas que los convierten en carbonatos, diversas cal, para la agricultura”, comenta.
Pero también existen otras soluciones posibles para las conchillas, como las soluciones basadas en la naturaleza. “Por ejemplo, se podría devolver cierta cantidad de conchas al mar, de manera que contribuyan a mejorar el pH al alcalinizarlo. Esto también podría favorecer la sustentabilidad de los bancos naturales de chorito, que nos aportan la semilla para los cultivos”, explica.
“La idea es contar con una hoja de ruta para definir cómo valorizar toda la conchilla que genera la industria, considerando también aspectos normativos”, concluye.
Por su parte, el gerente de Operaciones de Landes Mussels, Aldo Soldano, destaca los avances logrados por la empresa en su área de mitilicultura mediante al Acuerdo de Producción Limpia (APL).
Según Soldano, cuando se adhieren al primer Acuerdo de Producción Limpia (APL) en 2020, comenzaron con un diagnóstico inicial que, si bien mostraba un alto estándar en
En el caso de Blumar, el gerente Legal y Cumplimiento Normativo de Blumar, Juan Pablo Oviedo, destaca los avances relevantes en sostenibilidad que ha logrado gracias a los Acuerdos de Producción Limpia (APL), tanto en el área de pesca como en acuicultura. Desde su adhesión al Acuerdo de Producción Limpia “Estrategia de Cambio Climático y Economía Circular para el Sector Salmonicultor”, en 2021, han vivido un proceso que ha aportado valor a sus operaciones, siempre con la sostenibilidad como eje.
“Ese acuerdo nos permitió trabajar de manera colaborativa para avanzar en diferentes temas, tales como la economía circular, cambio climático, medición de nuestra huella hídrica y huella del agua, relacionamiento comunitario y transparencia”, explican desde la empresa.
“De hecho, uno de los hitos más importantes fue alcanzar la meta de valorizar el 80% de nuestros residuos, algo que habíamos proyectado recién para 2027”, agregan.
A partir de ahí, detallan que se plantean un nuevo desafío, que es llegar al 90% de valorización de residuos a 2030.
Explican que esta gestión ha estado completamente alineada con su estrategia de sostenibilidad, que busca minimizar su impacto mediante una gestión eficiente de los recursos y el impulso de una economía circular.
En paralelo, expresan que hicieron un trabajo para estandarizar la medición de su huella de carbono corporativa. Esta vez, definieron la meta de reducir en un 30% las emisiones de alcance 1 y 2 hacia 2030, tomando como base sus niveles de 2020. Para lograrlo, se sumaron a la iniciativa Science Based Targets.
“Todo esto, como parte de un camino que hemos emprendido en equipo, y que nos motiva a seguir empujando una
salmonicultura más responsable y conectada con los desafíos ambientales”, detallan.
Desde la compañía resaltan que uno de los enfoques principales ha sido la mejora en la eficiencia de sus operaciones. “Hemos trabajado en mejorar nuestra excelencia operacional, tanto en los centros como en las plantas de proceso, lo que se ha traducido en mayor eficiencia, mejor control de costos y decisiones de compra más responsables”.
Especifican que algunas de las iniciativas más relevantes han sido el desarrollo e implementación del Manual de buenas prácticas circulares de farming, y la primera medición de su huella hídrica en el segmento de salmones, como parte del Acuerdo de Producción Limpia.
“Este análisis incluyó todas nuestras instalaciones, propias y externas, y nos permitió entender con precisión cómo y dónde estábamos utilizando el agua, para luego aplicar mejoras con un enfoque sostenible”, afirman.
Por otro lado, desde Blumar mencionan que han avanzado en la gestión de residuos con una lógica de economía circular, logrando valorizar en 2024 el 90,8% de sus residuos: reciclan plásticos como boyas y flotadores, valorizan metales, papel, cartón, y se aseguran de reducir al mínimo los residuos que van a relleno sanitario.
El gerente Legal y de Cumplimiento Normativo de la compañía, Juan Pablo Oviedo, agrega que durante 2024 comenzaron a implementar planes de reciclaje de residuos
orgánicos en los centros de cultivo, con el objetivo de reducir al máximo sus residuos domiciliarios.
Asimismo, añaden que, durante el 2024, tanto el área Farming (Piscicultura, Bodega, Oficinas y Centros de Cultivos) como el área planta (planta Colón y oficinas corporativas) lograron certificar su sistema de gestión energética bajo estándar ISO 50001.
“El Acuerdo de Producción Limpia es una herramienta clave para empujar cambios concretos en la industria acuícola”, aseguran.
“Los valoramos como un compromiso formal, y una hoja de ruta que nos ha permitido alinear nuestras operaciones con metas ambientales claras y medibles, trabajando de forma colaborativa con otras empresas, organismos públicos y territorios”, especifican.
Gracias al APL, han avanzado en temas que antes eran difíciles de abordar de manera individual, como la estandarización de la medición de huellas ambientales o la incorporación más decidida de prácticas de economía circular.
Detallan que son acuerdos que les impulsan a movernos, a innovar, a revisar procesos y, sobre todo, a trabajar de forma más colaborativa.
“Áreas como abastecimiento, medioambiente, comunidades, comunicaciones, operaciones y sostenibilidad, se han involucrado activamente, lo que ha elevado nuestro estándar general y ha relevado una cultura de mejora continua en toda la empresa”, concluyen.
“El Acuerdo de Producción Limpia es una herramienta clave para empujar cambios concretos en la industria acuícola”, Juan Pablo Oviedo, gerente Legal y Cumplimiento Normativo de Blumar.
Trabajadores acuícolas.

SUBPESCA PRESENTA AÑO A AÑO EL ESTADO DE LAS PESQUERÍAS A NIVEL NACIONAL, EN CIFRAS CORRESPONDIENTES AL AÑO
ANTERIOR. EN SU VERSIÓN 2025, SE DESTACA QUE MÁS DEL 60% DE LA PESCA INDUSTRIAL SE MANTIENEN EN TORNO AL ÓPTIMO BIOLÓGICO.
El informe “Estado de situación de las principales pesquerías chilenas”, emanado desde la Subsecretaría de Pesca y Acuicultura (Subpesca), fue publicado a fines de marzo con los datos de 2024. Este evidencia que un 54% de las 24 pesquerías -que cuentan con estado de situación actualizado- se encuentran en un estado saludable, vale decir, que están en plena explotación (11) o subexplotadas (2). En tanto, un 33% de las pesquerías (8) se encuentran en estado de sobrexplotación y el 13% (3) en condición de agotada. El documento también da cuenta que, actualmente, existen 36 Comités de Manejo y se destaca el establecimiento de 23 Planes de Manejo promulgados y en funcionamiento. Además, da cuenta de la existencia de 11 Planes de Reducción del Descarte y Captura de la Pesca Incidental, los cuales incluyen a 17 pesquerías industriales y artesanales de especies pelágicas, crustáceos, demersales y de aguas profundas.
Respecto de la pesquería de jurel en la actualidad, el Comité Científico ha catalogado al recurso en un estado de conservación Saludable, ubicando las estimaciones de biomasa desovante en torno a los 17,7 millones de toneladas para el año
2024, lo que corresponde a un 98% sobre el nivel de la Biomasa Desovante en el Rendimiento Máximo Sostenido (RMS). Por ello, y en el marco de la 13º reunión de la Comisión, que se desarrolló en febrero de este año en Santiago, Chile, se hicieron presentes diversos argumentos científicos que permitieron un aumento del 25% para este año 2025, lo que se traduce en 1.552.500 toneladas, de las cuales 1.419.119 toneladas son asignadas a los países miembros, ante los cuales Chile posee un 66% de participación.
Consultados por Revista AQUA, desde la Subpesca destacan que el documento incluye cuatro pesquerías que presentaron una mejoría en su estado respecto del año 2023. Estas son: El bacalao de profundidad (Arica - 47°L.S), que pasó de Sobreexplotada a Plena Explotación; la jibia (Arica- Magallanes), de Sobreexplotada a Plena Explotación; la sardina austral (Los Lagos), de Sobreexplotada a Plena Explotación; y la sardina austral (Aysén), que pasó de Plena Explotación a Subexplotación.
“Esta versión incorporó además una nueva pesquería de recursos crustáceos-bentónicos: El centollón (Los LagosMagallanes), debido a la disponibilidad de información y a la relevancia que tiene este recurso en dicha zona”, añaden desde la Subpesca.
El documento también destaca la actualización realizada en 2024, al Plan Sectorial de Adaptación al Cambio Climático en Pesca y Acuicultura (PSACCPA). “También se da cuenta en

este reporte de la existencia de once Planes de Reducción del Descarte y Captura de la Pesca Incidental, los cuales incluyen a 17 pesquerías industriales y artesanales de especies pelágicas, crustáceos, demersales y de aguas profundas”, remarcan.
“Asimismo, se da cuenta que actualmente existen 36 Comités de Manejo y, esta edición particular, cuenta con un apartado respecto a la actual situación del jurel, y los auspiciosos resultados obtenidos ante la Organización Regional de Ordenación Pesquera del Pacífico Sur (SPRFMO por sus siglas en inglés, South Pacific Regional Fisheries Management Organisation). Los que permitieron la adopción de un nivel de cuota superior a la históricamente adoptada y acordada por la instancia integrada por Chile y otros 16 países miembros, tomando el acuerdo de un aumento del 25% para este año 2025, cuota ante la cual nuestro país posee un 66% de participación”, reiteran desde la Subpesca.
PESCADORES INDUSTRIALES DEL
En tanto, la Asociación de Pescadores Industriales del Biobío, destacan que, “considerando las 24 pesquerías que cuentan con estado de situación actualizado, el 54% de ellas se encuentran en un estado saludable, manteniendo prácticamente la misma situación del año anterior. Esto, en virtud de los procedimientos de manejo establecidos en el marco de la actual Ley de Pesca, como la puesta en marcha de los Comités Científicos Técnicos y los Comités de Manejo, que han permitido tener una orientación científica y ecosistémica en la toma de decisiones”.
“Si nos enfocamos en la macrozona centro sur de Chile, el 63% de las pesquerías en las que tiene participación la pesca industrial del Biobío, ya sea a través de la captura o el procesamiento de estos recursos, se encuentran sanos. De ellas, tanto el camarón nailon, el langostino amarillo y colorado, además del jurel, se encuentran certificadas por la Marine Stewardship Council (MSC), dando cuenta del trabajo sostenido por realizar capturas bajo estándares sustentables”, añaden desde el gremio.
Recuerdan que la merluza común, en tanto, aún se encuentra en estado de sobreexplotación, debido a que los objetivos de manejo no han sido suficientes para lograr su recuperación producto del alto nivel de pesca ilegal al que está sometida, principalmente en la región del Maule.
Mientras que la sardina común pasó de estar en plena explotación en 2023 a ser catalogada como sobreexplotada en 2024. “Aquí hay que ser categóricos en señalar que las determinaciones de la Subpesca permitieron operar gran parte de la temporada con recursos de sardina común de baja talla, con un alto volumen de captura de ejemplares juveniles, contribuyendo, por lo tanto, al fenómeno de sobreexplotación”, remarcan los industriales del Biobío.
“Por último, estimamos fundamental que la Subsecretaría avance en la determinación de los Puntos Biológicos de Referencia de las 20 pesquerías, principalmente correspondientes a recursos bentónicos, de las que aún se desconoce su estado de conservación real. También es urgente implementar planes “Un 54% de las 24 pesquerías que cuentan con estado de situación actualizado, se encuentran en un estado saludable”, Subpesca.
Planta de proceso pesquera.
Con los nuevos fraccionamientos, al aumentar la porción artesanal, particularmente en el caso del jurel, éste tendrá como destino la fabricación de harina de pescado y no los alimentos”, Pescadores Industriales del Biobío.

de recuperación para aquellas que se encuentran en estado de agotamiento y sobreexplotación”, agregan.
En cuando al impacto del proyecto de nueva legislación, los Pescadores Industriales del Biobío afirman que la Ley de Pesca vigente tiene un sello que la caracteriza enfocado en la sostenibilidad; ha promovido la implementación de diferentes medidas de administración pesquera e incorporado a los Comités Científicos Técnicos para la toma de decisiones. “Pero también, ha creado instancias consultivas como son los Comités de Manejo, los Consejos Zonales de Pesca y el Consejo Nacional de Pesca, que han sido fundamentales para promover una actividad sustentable”.
Afirman que es difícil proyectar el impacto de cambios normativos que aún no están vigentes, pero ya sea por efectos de nuevas distribuciones de cuotas o por una reforma a la actual ley, “la responsabilidad en la extracción de los recursos debe ser un componente prioritario, tanto para quienes nos dedicamos a la actividad pesquera, como también para los entes fiscalizadores. Por ello, el trabajo de Pescadores Industriales del Biobío está certificado con sellos internacionales que acreditan su pesca sustentable y esperamos que sean parámetros que constituyan un estándar para toda la pesca nacional”.
Enfatizan además la situación del jurel, donde Chile se ha transformado en el país con la mayor cuota a nivel mundial, gracias a su manejo sostenible y responsable. “Durante 2024, la flota de las empresas socias de Pescadores Industriales del Biobío capturaron 520.000 toneladas de jurel, de las cuales el 82% se destinó a elaborar productos de consumo humano, lo que se tradujo en más de 340.000 toneladas de congelados y más de 16.000 toneladas de conservas”.
“No obstante, con los nuevos fraccionamientos, al aumentar la porción artesanal, particularmente en el caso del jurel, éste tendrá como destino la fabricación de harina de pescado y no los alimentos que incorporan mayor valor agregado y alta demanda de mano de obra. Es decir, significaría un retroceso para la industria de alimentos ligada a la pesca en la región del Biobío”, advierten.
Desde 2013, la pesca industrial, basada en la actual legislación, impulsa la recuperación del sector y la estabilidad de las biomasas. No obstante, el gremio de la industria, Sonapesca, se suma a la advertencia de la academia y los comités científicos sobre el impacto de la normativa de remanentes y el adelanto de la temporada de sardina, “lo que con toda probabilidad traerá consecuencias los próximos años”, sostienen.
En pleno debate sobre el fraccionamiento pesquero entre el sector artesanal e industrial, considerado como el corazón de la ley de Pesca, propuesto por el Ejecutivo, que a la fecha de cierre de este reportaje, está ad portas de finalizar su tramitación en Comisión Mixta, la Sociedad Nacional de Pesca (Sonapesca) presentó un informe, basado exclusivamente, en la información generada por los comités científicos, que evidencia la recuperación del sector desde la implementación de la legislación vigente en 2013.
El estudio de las diversas pesquerías en Chile da a conocer el estado de éstas donde opera la pesca industrial, destacando que la normativa actual ha permitido mantener los recursos en niveles, en torno al Rendimiento Máximo Sostenible (RMS), concepto que ha sido adoptado por organizaciones internacionales como la FAO (Organización de las Naciones Unidas para
la Alimentación y la Agricultura) y forma parte de los principios de gestión pesquera en muchos países, incluyendo Chile.
El análisis muestra que 11 de 17 pesquerías, que representan un 60,4% del total, se mantienen en torno a su nivel óptimo biológico, con ocho de ellas por encima del RMS.
En particular, el mayor aumento lo tuvo el jurel, que ha experimentado una recuperación de 407,7% desde 2013, a pesar de una leve baja comparada con 2023 (-5%). Este progresivo avance le permitió obtener la certificación internacional del Marine Stewardship Council (MSC), uno de los estándares en sostenibilidad más exigentes del mundo, posicionándola como la pesca sostenible más grande de Latinoamérica en 2018.
“La participación de la industria en el jurel es de un 90,8% y hay un trabajo de más de una década sobre este recurso, en un esfuerzo conjunto entre el mundo científico, la Organización Regional de Pesca y sus Estados y la industria pesquera nacional, recuperando y certificando la pesquería bajo estrictos parámetros de sustentabilidad”, indican desde el gremio en el informe.
Debido a estos buenos resultados, actualmente existen doce pesquerías certificadas en sustentabilidad, ocho de ellas con MSC y otras cuatro con Marine Trust.
Por su parte, la anchoveta de las regiones de Valparaíso y Los Lagos sigue mostrando una sostenida recuperación, alcanzando un nivel significativamente superior al RMS, lo que indica que su biomasa está por encima del nivel sostenible y en un estado óptimo para su explotación.
“Sin embargo, en el último tiempo se ve una disminución en

la talla, es por ello, que se debe considerar los efectos que podrían generar una nueva ley de remanentes”, afirma el gremio.
Sonapesca destaca que tres pesquerías pelágicas redujeron su biomasa en 2024 respecto al año anterior, alcanzando el límite inferior del RMS. Las especies afectadas son la anchoveta de Arica y Parinacota a Antofagasta, la anchoveta de Atacama y Coquimbo, y la sardina común desde Valparaíso hasta Los

“Los desembarques están por debajo del 50% de la cuota global, lo cual hace evidente que no existe un problema de sobrepesca”, Sonapesca.
“Compartimos la preocupación de la academia y de los comités científicos sobre la urgente necesidad de evaluar los efectos de estas leyes”, Sonapesca.
Lagos, que pasaron de un estado de subexplotación a sobreexplotación por primera vez desde 2016. El informe técnico advierte que la disminución de la anchoveta entre las regiones de Arica y Parinacota y Antofagasta podría estar relacionada con diversos factores, entre ellos, cambios oceanográficos como el fenómeno de El Niño y un aumento en la presión de la pesca artesanal, un patrón que también se ha observado en las regiones de Atacama y Coquimbo.
Asimismo, el reporte aclara que “la pesca industrial no ha capturado sus cuotas, y los desembarques están por debajo del 50% de la cuota global, lo cual hace evidente que no existe un problema de sobrepesca. De hecho, hasta septiembre de 2024, la flota industrial no registró capturas debido a la concentración del recurso dentro de las primeras 5 millas, reservadas para la pesca artesanal”.
Por su parte, el análisis advierte que la sardina común desde Valparaíso hasta Los Lagos también ha disminuido, coincidiendo con la aplicación de la ley de remanentes del año anterior, un aspecto que ha sido señalado como una alerta por los comités científicos.
Cabe recordar que en el Reporte Técnico n°3/2024 realizado el 3 y 4 de junio, se estableció que: “El comité en pleno está de acuerdo en señalar que la incorporación de los remanentes en la estimación (…) carece de sentido biológico y fue una iniciativa política justificada en su momento por las consecuencias de la pandemia en la actividad de pesca artesanal. Por otra parte, contraviene el principio precautorio puesto que se demanda aplicar incluso en recursos sobreexplotados en franca contradicción con la LGPA”.
“Por ello, compartimos la preocupación de la academia y de los comités científicos sobre la urgente necesidad de evaluar los efectos de estas leyes. A lo anterior se suma las medidas que adoptó durante 2025 la autoridad para adelantar la temporada de pesca de sardina común, lo que está impactando fuertemente la fracción juvenil del stock, lo que con toda probabilidad traerá consecuencias los próximos años”, alertan desde Sonapesca.
“Esperamos que con los cruceros de prospección realizados entre enero y marzo de 2025, actualicen la información y la situación mejore en los pelágicos pequeños”, concluye el análisis del gremio.
CUADRO

*Fuente: Subpesca.
DESDE ESTE NÚMERO, REVISTA AQUA ABRIRÁ ESTA NUEVA
SECCIÓN CON LOS INDICADORES CLAVE DE LAS EXPORTACIONES
DE LA INDUSTRIA DE SALMÓNIDOS Y MITÍLIDOS.
Fuente: InfoTrade
Ene-Mar 2025
Ene-Mar 2024
Fuente: InfoTrade
Ene-Mar 2025
En Arabia Saudita

Bioled Photoperiod firmó un importante acuerdo de representación con Tilad Group, holding empresarial con sede en Riad, especializado en soluciones sostenibles para diversas industrias, incluyendo
Sistemas RAS a gran escala
la acuícola. Esta alianza permitirá que los equipos y servicios de Bioled estén disponibles para los proyectos actuales y futuros en Arabia Saudita y el resto de los países del GCC (Gulf Cooperation Council), aportando a una acuicultura más eficiente, responsable y alineada con los objetivos de sostenibilidad de la región.
La gerente general de Bioled, Cristina Navarro, destacó la relevancia de este acuerdo. “Este hito nos permite llevar nuestra tecnología a un mercado dinámico y en expansión. Arabia Saudita está liderando importantes iniciativas en acuicultura y estamos seguros de que seremos un socio estratégico para
potenciar la productividad y sostenibilidad de los productores locales”. En tanto, el líder del Área de Acuicultura de Tilad Group, Franco Cerda, expresó que “conocemos la calidad e impacto de las soluciones de Bioled y estamos convencidos de que serán un gran valor para nuestros clientes. Esta alianza refuerza nuestro compromiso de promover tecnologías de vanguardia en la industria acuícola saudita”. Este acuerdo consolida aún más la presencia internacional de Bioled, cuyos sistemas ya operan en más de 15 países con algunas de las principales productoras acuícolas a nivel mundial.
Innovasea anunció que ha contratado a Miguel Martin para unirse al equipo de diseño de sistemas de recirculación en acuicultura (RAS), aportando casi una década de experiencia en acuicultura como administrador y diseñador de estas instalaciones.
Martin trabajó anteriormente en las empresas noruegas Nofitech y Pure Salmon Technolgy, contribuyendo en proyectos que abarcan todas las fases del proceso productivo del salmón, incluyendo centros de cultivo ubicados en Noruega, Escocia, Japón, las Islas Feroe, Brunéi y los Estados Unidos.
“Miguel aporta una experiencia invaluable en el diseño de sistemas a gran escala para la producción de salmón”, afirmó el gerente general de Innovasea Chile, Juan Pablo Barrales, agregando que “estamos encantados de darle la bienvenida al equipo y aprovechar sus conocimientos”.
Innovasea ofrece una amplia gama de equipos, tecnología y pericia para centros de cultivo acuícolas tanto terrestres como en mar. Martin se unirá a un equipo dedicado con amplia experiencia en el diseño y suministro de sistemas de recirculación en agua dulce y salada, adaptados a las necesidades de cada cliente.

Se une al equipo de Innovasea para fortalecer el desarrollo de soluciones personalizadas.
“Estoy muy emocionado por formar parte de este equipo tan talentoso y orientado a los detalles”, añadió Martin. “Me motiva mucho el desafío de comprender y resolver las necesidades únicas de cada centro para así elaborar soluciones personalizadas, ayudando a los clientes alcanzar sus objetivos. El mercado chileno representa una gran oportunidad para el desarrollo de la acuicultura y estoy entusiasmado de contribuir a impulsar ese progreso”.
Oxxean Puerto Chacabuco da inicio a su Brigada de Emergencia con exitoso simulacro de incendio / Resiter firma acuerdo estratégico con Sealand Advanced Aquaculture / Impulsan iniciativa para debatir sobre la edición de genes en acuicultura
Con el objetivo de diversificar la matriz energética de la región de Aysén y contribuir al desarrollo sostenible de la industria acuícola, DVS Tecnología presentó ante la Mesa Regional de Energía su prototipo de generación de energía mareomotriz, basado en el aprovechamiento de las corrientes marinas como fuente limpia y renovable.
Esta innovadora solución, desarrollada por DVS desde 2012, está orientada para reducir la dependencia de combustibles fósiles y mejorar la autonomía energética, particularmente en zonas aisladas que hoy enfrentan un suministro limitado, intermitente y costoso. “No solo buscamos entregar energía renovable y continua a las comunidades
costeras de Aysén, sino también aportar a la consolidación de una industria acuícola más sostenible, con mayor independencia energética y menor huella ambiental”, señaló el gerente general de DVS Tecnología, Daniel Vega.
El Prototipo desarrollado por la empresa contempla la entrega de un catamarán, hélices y componentes clave para su implementación para una prueba de campo real, lo que permitiría en una primera etapa, verificar la capacidad energética del prototipo para estimar su escalamiento a nivel industrial. Este avance representa una alternativa real y concreta para enfrentar los desafíos energéticos que limitan el desarrollo productivo regional.
Encuentro internacional de VeHiCe
Este proyecto apunta directamente a la diversificación energética de Aysén, pero también podría fortalecer una actividad clave como la salmonicultura. Cabe destacar que el país cuenta con uno de los mayores potenciales de energía marina a nivel mundial.

El futuro de la salud acuícola se reúne

La cuarta edición del 4th International Seminar ’25: Fish Pathology, Toxicology, RAS, and Animal Welfare congregó en el Teatro del Lago en Frutillar (región de Los Lagos) a destacados expertos, investigadores y empresas innovadoras del sector acuícola. Este evento organizado por el laboratorio chileno especialista en histopatología, VeHiCe. se ha consolidado como una instancia clave para compartir avances, buenas prácticas y soluciones a los desafíos más urgentes en salud acuícola, entre ellos la nefrocalcinosis, patologías no infecciosas, deformidades estructurales y el bienestar animal.
El seminario ofreció una experiencia internacional con ex-
posiciones técnicas, workshops interactivos y espacios de networking que permitieron a los asistentes conectar con líderes globales, explorar tecnologías emergentes y debatir sobre los nuevos horizontes en sistemas de recirculación acuícola (RAS) y diagnósticos avanzados.
Durante la inauguración, el alcalde de Puerto Montt, Rodrigo Wainraihgt, agradeció la realización del encuentro en la ciudad y destacó “la importancia de la industria del salmón para Puerto Montt, la Región de Los Lagos y el país entero, junto con la iniciativa del Plan Salmón a 50 Años, que impulsamos junto a las regiones de Aysén y Magallanes”.
Este cuarto seminario internacional reafirmó la relevancia de la colaboración científica global para avanzar en prácticas acuícolas sostenibles, responsables y basadas en la evidencia. Un encuentro donde el conocimiento y la innovación se unen para enfrentar los desafíos presentes y futuros del sector.
PSP Chile impulsa el futuro con innovación: Soluciones de alto impacto a través de la I+D+i / ¡A Noruega! Convocan a postular a la feria AquaNor 2025 / PAT Industrial refuerza presencia en la salmonicultura con nuevas soluciones de automatización
Para el sistema de surgencia

La compañía destaca esta tecnología como una estrategia clave para mitigar el bloom de algas.
Soldasur ha alcanzado un hito significativo al instalar más de 2.000 equipos de surgencia en centros de cultivo de salmón. Esta avanzada tecnología es crucial en la lucha contra el fenómeno del bloom de algas nocivas, que representa un desafío creciente para la industria salmonicultora del país.
La acuicultura en Chile ha experimentado un rápido crecimiento en los últimos años, lo que ha generado un aumento en la frecuencia e intensidad de los blooms de algas. Este fenómeno natural afecta la calidad del agua y, en consecuencia, la salud de los peces.
Tras crecimiento sostenido
Frente a esta problemática, la surgencia artificial se ha consolidado como una solución innovadora. Al replicar el proceso natural de ascenso de aguas profundas y frías, ricas en nutrientes, esta tecnología permite reducir la proliferación de microalgas nocivas y mejorar las condiciones ambientales dentro de los centros de cultivo.
Los resultados de los equipos de surgencia artificial de Soldasur han sido altamente satisfactorios. Entre sus principales beneficios se incluyen la disminución de la temperatura superficial del agua en hasta 2-4°C, lo cual limita el crecimiento de especies de fitoplancton nocivas como Alexandrium catenella y Pseudo-nitzschia spp. Además, se ha logrado un aumento en la concentración de oxígeno disuelto en el agua (>6 mg/L), lo que favorece el bienestar de los peces y optimiza su crecimiento. También se ha constatado una reducción en los episodios de anoxia, dispersando y diluyendo las microalgas y contribuyendo a la estabilidad del ecosistema marino.
Garware Technical Fibres Chile incorporó a Ricardo Gálvez Oyarce, reforzando así al equipo comercial de Chile, buscando contribuir al crecimiento y la capacidad competitiva de la empresa en un mercado clave.
“En Chile hemos experimentado un crecimiento sostenido durante la última década y con nuestra innovación, hemos transformado los productos utilizados en la industria salmonicultora. La llegada de Ricardo busca fortalecer el crecimiento y expansión de Garware, en línea con nuestra estrategia comercial y el objetivo de mantener y profundizar nuestro servicio al cliente. Nuestro proceso de innovación comienza con la voz del cliente y trabajamos en estrecha colaboración. La experiencia y las habilidades de Ricardo nos ayuda-
rán a cumplir nuestra misión de ofrecer productos innovadores, enfocados en aplicaciones que aumenten la rentabilidad del negocio de nuestros clientes”, afirmó el presidente de Garware Technical Fibres para las Américas, Gopakumar Menon. Ricardo Gálvez es ingeniero civil industrial de la Universidad de Chile con un magister en administración de empresas de la Universidad Austral de Chile, quien previamente se desempeñó en áreas como agenciamiento marítimo, gestión de residuos industriales, desarrollo de nuevas líneas de negocio y de nuevos mercados, proveedor de productos y servicios para la salmonicultura y en el área comercial de Ventisqueros y de Procter & Gamble.

“Garware cuenta con productos de alta calidad y está implementando las mejores prácticas en innovación, sustentabilidad, expansión de mercados y un excelente trabajo en equipo. Me abocaré en aportar valor al equipo comercial”, precisó Gálvez.
Aquabyte implementa sistema automatizado para evaluar maduración del salmón en Islandia / Nuevo liderazgo en Asenav asume estratégica gerencia / Carlos Lobos de PHARMAQ Analytiq: “La gran ventaja de este servicio es su aplicación in situ”

Revista AQUA se publica doce veces al año.
Revista AQUA se publica doce veces al año.
VENTAS
VENTAS
Gerente General
Gerente General
Cristián Solís A.
Cristián Solís A.
Gerente Comercial
Gerente Comercial
Alejandra Cortés L.
Alejandra Cortés L.
Encargado Control y Gestión Comercial
Encargado Control y Gestión Comercial
Jonatan Bustos G.
Jonatan Bustos G.
Ejecutivas Comerciales
Ejecutivas Comerciales
Rosemarie Cortes Dörner
Andrea Jiménez, Ejecutiva Comercial
E-mail: rcortesd@b2bmg.cl
E-mail: ajimenez@b2bmg.cl
Tel.: +56 9 35715631
Tel.: +56 9 9895 6806
Francesca Massa Arenas
Rosemarie Cortes Dörner
E-mail: fmassa@b2bmg.cl
E-mail: rcortesd@b2bmg.cl
Tel.: +56 2 2757 4289, +56 9 7479 0735
Tel.: +56 9 35715631
Karla Sambra Casanova
Francesca Massa Arenas
E-mail: ksambra@b2bmg.cl
Tel.: +56 2 2757 4200, +56 9 8848 3198
E-mail: fmassa@b2bmg.cl
Tel.: +56 2 2757 4289, +56 9 7479 0735
Carola Correa Jélvez
E-mail: ccorrea@b2bmg.cl
Carola Correa Jélvez
Tel.: + 56 2 2757 4298, +56 9 7218 3751
E-mail: ccorrea@b2bmg.cl
Tel.: +56 2 2757 4298, +56 9 7218 3751
Yanis Ramirez
E-mail: yramirez@b2bmg.cl
Sebastián Campos
Tel.: +56 9 78830108
Product Manager de iMercados
E-Mail: scampos@b2bmg.cl
Francisca Araya Araya
Tel.: +56 9 7622 7022
KAM Inteligencia de Mercados
E-mail: faraya@b2bmg.cl
Yusbelly Aponte Albarrán
Tel.: +56 2 2757 4294, +56 9 3373 3798
Supervisora Comercial EmpleosAqua
E-mail: mailto:yaponte@b2bmg.cl
Yusbelly Aponte Albarrán
Tel.: +56 65 247 0107; +56 9 6526 1088
KAM portal EmpleosAqua.cl
E-mail: yaponte@b2bmg.cl
Patricia González Morales
Tel.: +56 65 247 0107, +56 9 6526 1088
Ejecutiva Comercial EmpleosAqua
E-mail: pgonzalez@b2bmg.cl
Suscripciones
Tel.: +56 65 247 0107; +56 9 4926 9414
Aqua es una publicación independiente, que no cuenta con patrocinios de ninguna naturaleza. La revista sólo esta disponible por suscripción.
Suscripciones
Aqua es una publicación independiente, que no cuenta con patrocinios de ninguna naturaleza. La revista sólo esta disponible por suscripción.
En Chile, la revista se distribuye en forma gratuita a profesionales y ejecutivos de compañías acuícolas y pesqueras que cultivan, extraen, comercializan y/o procesan recursos hidrobiológicos y ejecutivos de organismos oficiales relacionados.
Aqua se reserva el derecho de asignar la cantidad de suscriptores por empresa, toda persona que no califique en ninguna categoría anterior, podrá tomar una suscripción pagada.
En Chile, la revista se distribuye en forma gratuita a profesionales y ejecutivos de compañías acuícolas y pesqueras que cultivan, extraen, comercializan y/o procesan recursos hidrobiológicos y ejecutivos de organismos oficiales relacionados. Aqua se reserva el derecho de asignar la cantidad de suscriptores por empresa.
Solicite su suscripción a: Rubén VIllarroel (rvillarroel@ b2bmg.cl)
Solicite su suscripción por internet en: www.Aqua.cl o a: Rubén VIllarroel (rvillarroel@b2bmg.cl), Tel.: +56 2 2757 4222 Suscripción Chile: anual $47.600 (IVA incluido), estudiantes: anual $23.800 (IVA incluido). Suscripción extranjero: EE.UU y América del Sur: US$204, Centroamérica y Canadá: US$250; Europa y resto del mundo: US$280.
DIRECCIÓN
DIRECCIÓN
Santiago: Magnere 1540, of. 801, Providencia, Santiago. Teléfono: +56 2 2757 4200
Santiago: Magnere 1540, of. 801, Providencia, Santiago. Teléfono: +56 2 2757 4200
Puerto Montt : Benavente N° 550, Oficina 305, Edificio Campanario, Puerto Montt. Teléfono: +56 65
Puerto Montt : Benavente N° 550, Oficina 705, Edificio Campanario, Puerto Montt.
Teléfono: +56 65 - 225 69 25
Registro de Propiedad Intelectual N°89.315. Hechos los depósitos.
Todos los derechos reservados. Prohibida toda reproducción total o parcial de los contenidos de la revista sin autorización previa de B2B Media Group.
Registro de Propiedad Intelectual N°89.315. Hechos los depósitos. Todos los derechos reservados. Prohibida toda reproducción total o parcial de los contenidos de la revista sin autorización previa de





